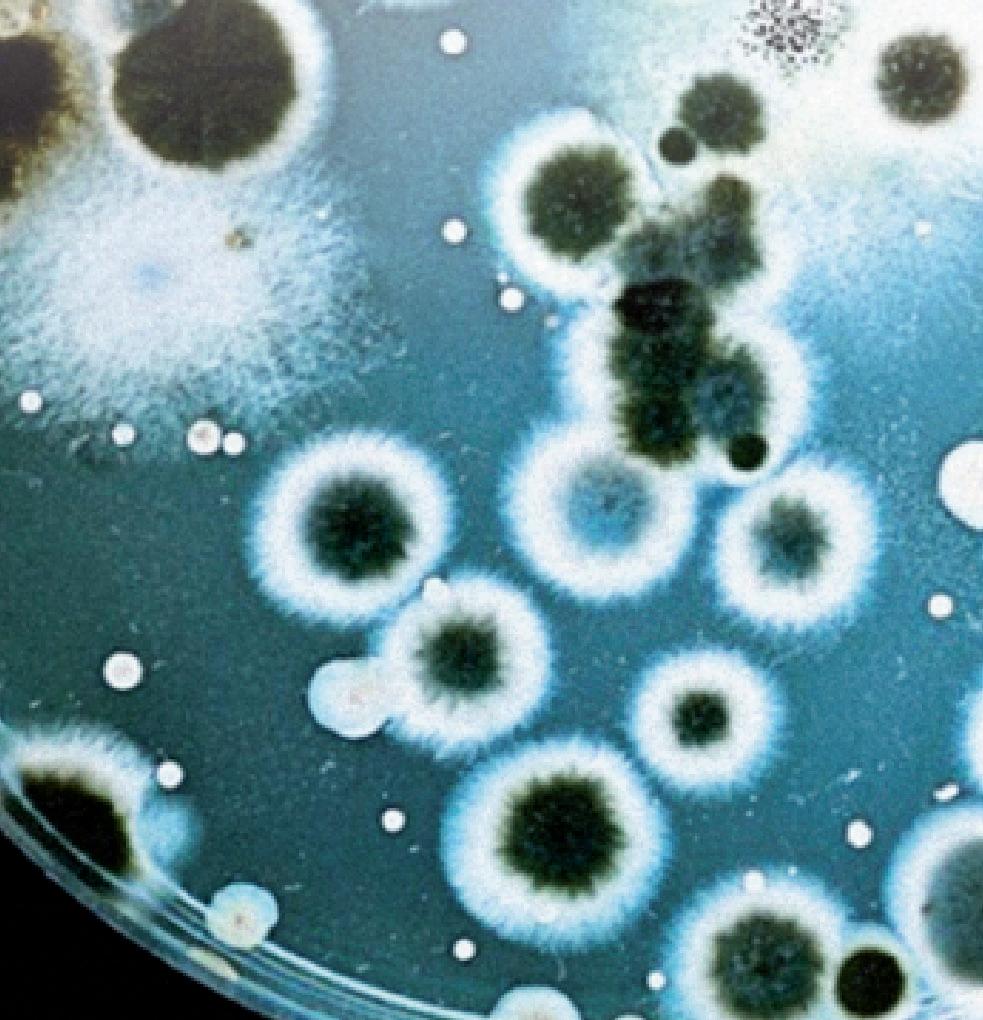

>> Caçada aos criminosos que fugiram do presídio federal de Mossoró custou, em média, R$ 121 mil por dia. O gasto maior foi da Polícia Rodoviária Federal, no total de R$ 3,3 milhões.
TRANSNORDESTINA
Ferrovia terá papel importante para o desenvolvimento das regiões Norte e Nordeste
COLUNA CÉSAR SANTOS OPORTUNIDADE
Escolhido outra vez, Codes terá a oportunidade de pacificar a Ufersa
Professor doutor Rodrigo Codes foi eleito pela comunidade acadêmica e agora espera assumir a Reitoria da Ufersa.
Principal 5
Mossoró registra mais de 7 mil inscritos em concurso nacional
Concurso unificado para várias áreas da administração pública federal despertou o interesse de quem busca oportunidades.
1
De volta ao PSB, Larissa pode ser candidata em disputa majoritária
>> Ex-deputada e ex-vereadora vai assumir a presidência estadual do partido. Em Mossoró, a sigla estava sob o comando do prefeito Allyson Bezerra, que agora procura REDE para colocar candidatos à Câmara.
Principal 3


Organização: Clauder Arcanjo
Escritor, membro da Academia de Letras do Brasil edmilson.caminha@gmail.com
Ao longo da História, o Itamaraty transcendeu o papel institucional que lhe cumpre exercer – representar diplomaticamente as posições políticas e os interesses econômicos do Brasil no concerto das nações – para também se fazer um centro de primazia acadêmica, à altura do que há de melhor no magistério universitário brasileiro. Prova disso são os homens e mulheres diplomatas que o honram e engrandecem, ontem como hoje: Guimarães Rosa, Antônio Houaiss, José Guilherme Merquior, João Cabral de Melo Neto, Sérgio Paulo Rouanet, Vera Pedrosa, Alberto da Costa e Silva, Evaldo Cabral de Mello, Francisco Alvim, Lauro Moreira, Carlos Henrique Cardim, Paulo Roberto de Almeida, João Almino, Gisela Maria Padovan, Sérgio Danese, Gonçalo Mourão, José Maurício Bustani e Irene Vida Gala, além de tantos outros. A par do desempenho das funções burocráticas e protocolares como embaixadores e cônsules, publicaram obras literárias (e muitos felizmente ainda as escrevem), dirigiram programas editoriais de relevo e possibilitaram o lançamento de periódicos que enriquecem a cultura brasileira.
Criada em 1993 por decreto do presidente Itamar Franco, a Comissão Nacional para as Comemorações do V Centenário do Descobrimento do Brasil foi presidida pelo embaixador Lauro Moreira, responsável pela publicação de três excelentes números da revista Rumos. Com o subtítulo “Os caminhos do Brasil em debate”, abria as páginas para a discussão de ideias, a livre defesa de pensamentos e de opiniões, longe do oba-oba demagógico que está mais para a propaganda de governos do que para o diálogo intelectual. Sob a direção do jornalista Dirceu Brisola e o saber do também jornalista Daniel Piza, um dos editores, não havia dúvida quanto à seriedade do projeto, como se lê na apresentação do diplomata Lauro Moreira:
A revista Rumos nasce com objetivos claros. Ela se insere na proposta da Comissão Nacional do V Centenário de fazer dos 500 Anos um momento de reflexão sobre caminhos e perspectivas do Brasil. (...) Como espaço de debates, Rumos será pluralista e crítica. Cada número privilegiará um tema, tratado por intelectuais de diferentes tendências. (...) Espero que Rumos contribua para mobilizar a sociedade bra-

sileira em torno de uma reflexão crítica sobre o significado de nossos quinhentos anos de história, com os olhos postos no futuro.
O primeiro número (dezembro de 1998 / janeiro de 1999), com o tema “Conflitos da identidade nacional”, traz longos e substanciosos ensaios de Jorge Coli, Olgária Matos, Carlos Guilherme Mota, Eduardo Portella, Renato Janine Ribeiro, Ismail Xavier e Rosa Maria Dias. Textos a que se somam uma entrevista com o professor João Luís Fragoso, poemas de Marly de Oliveira e a memória de Ferreira Gullar como uma das primeiras vítimas do AI-5, preso que foi no infausto dia 13 de dezembro de 1968. Que outra revista brasileira, mesmo as acadêmicas, reúne tanta gente boa logo na edição inaugural?
Para o número 2 (março / abril de 1999) escrevem, como resposta à pergunta “Quem és tu, Federação?”, intelectuais com a relevância de Francisco de Oliveira, Fernando Luiz Abrucio, Isabel Lustosa, Rui de Britto Álvares Affonso, Celso Furtado, Luiz Roncari, Milton Hatoum, Rubens Ricupero, Roberto DaMatta e Daniel Piza. O entrevistado é o filósofo José Arthur Giannotti, que, há 25 anos, defendia ideias que continuam válidas:
Acho que a primeira coisa a fazer seria pegar a borracha e limpar a Constituição. Uma emenda supressiva. Não uma constituinte, mas uma reforma geral para que a Constituição fosse mais do tipo americano, mais com princípios, deixando o resto para a lei ordinária. Com um capitalismo desse jeito, com luta social, vai-se adaptando a lei. Definem-se grandes princípios, sem imaginar que a Constituição vá garantir tudo. E conforme venha um governo mais de esquerda, promulga certas leis, em vez de mexer na Constituição. O detalhismo da Constituição não tem sentido. Em segundo lugar é a reforma política. Esse negócio de partido nanico é altamente prejudicial para a política. Ter um jogo político mais limpo não permite, por exemplo, aventureiros que chegam a matar gente. A reforma política é fundamental.
“Brasil / Portugal, o legado ambivalente” é o mote da terceira edição de Rumos (maio / junho de 1999), com estudos de Aspásia Camargo, Evaldo Cabral de Mello, Miriam Dohlnikoff,

Evanildo Bechara, João Almino, a portuguesa Graça Capinha, Jacqueline Hermann, Luís Antônio Giron e Leda Tenório da Motta. Entrevistado por Daniel Pizza, o historiador inglês Kenneth Maxwell não vê, hoje, afinidades maiores entre Brasil e Portugal:
O Brasil é muito grande, muito diversificado, multiétnico e multirracial, com uma experiência histórica que seguiu caminhos muito diferentes dos de Portugal, por mais de um século, para que essa identidade reflita a realidade. Os laços de idioma e história, o passado colonial comum, algumas continuidades institucionais e atitudes burocráticas obviamente continuam. Mas me espantei em minha primeira visita ao Brasil com o quanto ele é diferente de Portugal, da mesma forma como os Estados Unidos são muito diferentes, em vários sentidos, do tipo de mundo inglês onde cresci.
A capa não informa, como antes, “publicação da Comissão Nacional para as Comemorações do V Centenário do Descobrimento do Brasil”, mas apenas “publicação comemorativa do V Centenário do Descobrimento do Brasil”. Sinal, talvez, de que, por inveja ou por mesquinharia, já houvesse insatisfeitos com o brilho de Lauro Moreira à frente da Comissão, como a folclórica e ridícula figura do governo Fernando Henrique Cardoso que poria tudo a perder. Abandonou-se o belo programa de eventos culturais pela construção de uma réplica da caravela de Cabral, que afundou sem navegar sequer uma milha. Melancólico símbolo de como triunfam as nulidades, desde o tempo de Rui Barbosa. Assim naufragou a revista Rumos, que não chegou a padecer do “mal dos sete números”, como tantos bons periódicos brasileiros: foi morta aos três...
& & &
Em 2017, o presidente Michel Temer criou, por decreto, a Comissão Nacional do Bicentenário, responsável pelos eventos oficiais comemorativos dos 200

anos da Independência. Presidido pelo ministro da Cultura, o grupo jamais se reuniu, tão rapidamente se sucederam as nomeações para a chefia do ministério. Sabedor de que tudo resultaria em nada, o diplomata Paulo Roberto de Almeida, então presidente do Instituto de Pesquisa das Relações Institucionais, sugeriu a formação de um Grupo de Trabalho do Bicentenário da Independência, no âmbito do gabinete do à época ministro das Relações Exteriores, Aloysio Nunes Ferreira. O coordenador-adjunto, embaixador Carlos Henrique Cardim, propôs a edição de uma revista que ombreasse com os 49 números da Oceanos, publicada em Lisboa, entre 1989 e 2002, pela Comissão Nacional para as Comemorações dos Descobrimentos Portugueses. Criou-se, assim, a 200, cuja meta se patenteia na apresentação do editor Cardim:
A revista 200 é uma publicação periódica de divulgação de artigos sobre a Independência: textos já publicados, mas de difícil acesso, e textos originais. Contribui para uma visão mais ampla do processo, com ênfase na sua dimensão de relações exteriores. Colabora, assim, com a “Comissão Nacional do Bicentenário”. (...) Assim inspirada, a revista 200 propõe-se difundir “monografias conscienciosas”, principalmente do ângulo das relações exteriores.
“Muitas vezes o olhar estrangeiro enxerga mais nítido e seleciona melhor que a visão do nacional”, escreve o apresentador, para concluir com uma história:
No almoço oferecido pelo Presidente Tancredo Neves, em nossa Embaixada em Buenos Aires, em janeiro de 1985, em homenagem ao Presidente Raúl Alfonsín, Jorge Luis Borges, presença honrosa no ato, comentou ao Presidente Trancredo Neves duas coisas que impressionavam, e o tocavam forte sobre o Brasil: o livro de Euclides da Cunha, Os Sertões, e particularmente a frase do Hino da Independência: “Brava gente brasileira”, disse cantarolando. Tancredo ouviu com atenção e apreciou bastante. Borges – ao lado da mulher, María Kodama –, cego, e com bengala que trouxera dos pastores do Egito, viu claríssimo o espí-
rito e o sentimento que movem o Brasil.
Com data de outubro / dezembro de 2018, o primeiro número da 200 enfeixa páginas de Jean-Baptiste
Debret, Arno Wehling, Gilberto Freyre, Márcia
Regina Berbel, Raymundo Faoro, Carlos Lima Junior, Solange Ferraz de Lima, Pedro Calmon, José Murilo de Carvalho (com Lúcia
Bastos e Marcello Basile), Gonçalo Mourão, João Alfredo dos Anjos, Paulo Roberto de Almeida e Manuel Diegues Júnior. Capítulos primorosamente ilustrados, a comprovar a excelência do projeto e o apuro da edição.
Impressa pela gráfica em dezembro de 2018, a revista foi censurada pelo governo Jair Bolsonaro, que se empossaria um mês depois. Sobre a espantosa decisão, lembra o diplomata Paulo Roberto de Almeida:
Qual não foi a nossa surpresa quando a tropa de bárbaros que estava tomando posse do Governo e do Itamaraty, sob as ordens diretas do patético chanceler acidental, ordenou o “sequestro” – essa é a palavra – da revista e sua não distribuição. Depois, eu soube que foi ordenada a sua destruição, así no más
Sem lançamento nem circulação, nenhum exemplar da 200 chegou a leitores, a bibliotecas, a cadernos de cultura da imprensa. Não bastasse a asfixia, determinou-se a queima de toda a edição, como se regredíssemos aos autos de fé medievais, sob a loucura de infames que nos afrontaram como povo e nos comprometeram como nação. Milagrosamente, salvou-se a revista das chamas, para que ficasse como prova de que o bicentenário da Independência poderia ter-se comemorado de maneira digna, honrosa, decente.
Em 7 de setembro de 1822, Pedro I gritou, às margens do Ipiranga, “Independência ou morte!” Dois séculos depois, o insano Bolsonaro empunha um microfone em Brasília e puxa o coro de “Imbrochável! Imbrochável! Imbrochável!” Que, daqui a cem anos, não voltem os brasileiros a passar por essa vergonha. Quem sabe, então, possa o Itamaraty publicar sua grande revista, com o título 300, devidamente atualizado...


ELEIÇÕES 2024 / Ex-vereadora e ex-deputada estadual assume partido que era controlado pelo prefeito Allyson Bezerra
CÉSAR SANTOS
Da Redação cesar@defato.com
Seis anos após deixar o PSB, o rosadismo está de volta ao partido, no qual atuou durante 13 anos, no período de 2005 a 2018. Nesta sextafeira, 5, a ex-deputada estadual e ex-vereadora Larissa Rosado confirmou a filiação ao PSB, após entendimento com a direção nacional do partido. Nesta segunda-feira, 8, ela será recebida em Brasília pelo presidente da sigla, Carlos Siqueira. A reunião, provavelmente, oficializará Larissa na presidência do PSB do Rio Grande do Norte.
O retorno de Larissa à legenda socialista tem a interferência direta do PT, da governadora Fátima Bezerra, por consequência das eleições municipais deste ano. O PSB estadual, que estava sob o controle do ex-deputado federal Rafael Motta, vinha criando problemas em Natal e Mossoró, os dois maiores colégios eleitorais do RN, contrariando os interesses políticos da aliança dos partidos a nível nacional.
Em Natal, o próprio Rafael Motta se lançou précandidato a prefeito, em detrimento da postulação da deputada federal Natália Bonavides, nome do PT à sucessão na capital. Daí, o PSB abriu as portas para a saída de Rafael, que agora está filiado ao Avante. Por gravidade, a legenda ficou livre para apoiar Bonavides.
Em Mossoró, Rafael Motta havia dado o PSB ao prefeito Allyson Bezerra (União Brasil), que é adversário do PT e opositor ao governo Fátima Bezerra. Ele, o prefeito, colocou o seu auxiliar de ga-

binete, Wilson Fernandes, para presidir a sigla. Agora, Wilson será convidado a deixar o cargo ou, se quiser permanecer, seguir a nova orientação político-eleitoral.
Com o PSB nas mãos do rosadismo, o partido em Mossoró deverá perder a nominata à Câmara Municipal, que havia sido formada pelo prefeito Allyson. A informação no fim da tarde desta sexta-feira era que os précandidatos a vereador sairiam para o Rede, partido presidido no estado pelo exvereador João Gentil.
Em contato com o Jornal de Fato, Larissa Rosado afirmou que o PSB será aliado do PT, conforme orientação da direção nacional. O partido tem a vice-presidência da República, com Geraldo Alckmin, e faz parte do projeto liderado pelo presidente Luiz Inácio da Silva, que visa à reeleição em 2026. Por isso, a orientação para que as duas legendas sigam juntas nas eleições municipais, sobretudo em médios e grandes colégios eleitorais.
Em 23 de março de 2018, a então deputada estadual Larissa Rosado, com a sua mãe Sandra Rosado, que era vereadora, acertaram a saída do PSB para o PSDB, levando todo o grupo para a sigla tucana.
Naquele momento, o rosadismo estava encerrando uma parceria política de 13 anos com PSB. O grupo chegou ao partido socialista em 2005, pelas
mãos da então governadora Wilma de Faria (falecida em 2017), saindo do PMDB onde estava enraizado há décadas, sob a liderança do ex-deputado federal Vingt Rosado, pai de Sandra e avô de Larissa.
Foi no PSB que o rosadismo se aproximou de Eduardo Campos (falecido em 13 de agosto de 2014, em acidente aéreo, quando era candidato à Presidên-
Larissa Rosado é consciente que uma “revoada” de pré-candidatos a vereador do PSB, que deve ocorrer, praticamente inviabiliza uma candidatura sua à Câmara Municipal. Como hoje é o último dia do prazo de filiação partidária para quem vai disputar as eleições de 6 de outubro, não há tempo para o rosadismo conseguir formar uma chapa.
Isso, porém, não significa que Larissa Rosado esteja alijada das eleições munici-
pais 2024. Ela pode ser um nome para compor chapa majoritária, como candidata à prefeita ou à vice-prefeita. Larissa não admite essa hipótese de público, mas a federação partidária formada por PT/PCdoB/PV aceita a possibilidade.
“A única coisa que posso informar agora é que eu vou para uma reunião com Carlos Siqueira, na próxima segundafeira, para discutir o projeto do PSB do Rio Grande do Norte para as eleições municipais deste ano”, disse Larissa.

Tenho uma reunião com Carlos Siqueira para discutir o projeto do PSB para as eleições municipais”
cia da República) e fortaleceu laços políticos e de amizade. Sandra Rosado, na condição de deputada federal, fez parte do movimento pela indicação e nomeação de Ana Arraes, mãe de Eduardo Campos, para o cargo de ministra do Tribunal de Contas da União (TCU).
A transferência do rosadismo do PSB para o PSDB foi costurada pelo presidente do partido no RN, Ezequiel Ferreira de Souza, que também é presidente da Assembleia Legislativa.
Quatro anos depois, em
Ney Lopes
nl@neylopes.com.br
www.blogdoneylopes.com.br

Preço de medicamentos: causa oculta da morte
Tragicamente, os médicos nos dizem que muitos dos seus pacientes já não podem pagar os seus medicamentos. Como resultado, alguns ficam mais doentes. Outros morrem. O mais grave é que no mercado do mundo se verifica escassez recorde na produção de medicamentos, fazendo com que os países optem por alternativas, enquanto os pacientes mudam os tratamentos para medicamentos menos eficazes e enfrentam piores resultados. Uma situação de apreensão.
O problema é recorrente e generalizado: em 2022 e 2023, os órgãos nacionais de farmácias de 26 países europeus relataram escassez, com o quadro, piorando no ano passado. A questão se resume no seguinte: as grandes empresas farmacêuticas se concentram no desenvolvimento de medicamentos inovadores, que podem vender sob patentes e com altas margens.
Enquanto isso, os medicamentos genéricos estão fora de patentes e rendem menos lucro às empresas. Mais de 6% das vendas de prescrição perderão a proteção de patentes em 2028, o nível mais alto desde 2015. O resultado é que noventa e um por cento dos medicamentos prescritos nos EUA são genéricos, porém desaparecem para venda nas farmácias pelos baixos preços. É criado o “mercado partalelo”, que gera escassez pela produção baixa.
No Reino Unido, 99 medicamentos genéricos deixaram de ser produzidos. Isso afetou o fornecimento de medicamentos como terapias de reposição hormonal e medicamentos para o TDAH. Para os pacientes, a escassez, em última análise, traduz-se em um tratamento menos eficaz. Médicos em um estudo paquistanês de 2021 relataram que a escassez levou a atrasos no tratamento, complicações da doença e até mesmo risco de morte.
Quanto mais dependência de um produtor distante, mais vulnerável aumenta a possibilidade de escassez de medicamento. A dependência de fábricas chinesas para ingredientes farmacêuticos ativos contribuiu para a escassez sustentada de antibióticos na Europa em 2022, no período de restrições zero à Covid na China.
Nos países mais ricos, os sistemas são muitas vezes melhor equipados para se adaptar à escassez, obtendo medicamentos de outros lugares ou usando tratamentos alternativos. No entanto, três quartos dos grupos nacionais de farmácias da Europa pesquisados no ano passado disseram que a escassez levou a um tratamento pior, e 15% afirmaram que levaram a eventos adversos, como mais efeitos colaterais.
2022, o rosadismo trocou o PSDB pelo União Brasil, a convite do ex-senador José Agripino Maia. Pelo União, Sandra e Larissa foram candidatas à deputada federal e estadual, sem sucesso nas urnas.
Em 2023, Agripino tirou o comando do União Brasil de Mossoró das mãos do rosadismo e entregou ao prefeito Allyson Bezerra, obrigando o grupo a deixar o partido e, por gravidade, abrindo caminho para o retorno de Larissa e Sandra ao PSB.
Em longo prazo, à medida que as populações envelhecem e as condições crônicas aumentam, o crescimento global da demanda por medicamentos colocará mais pressão sobre as cadeias de suprimentos. A escassez de medicamentos afeta as pessoas que vivem em países de baixa renda, onde falta de pessoal e o financiamento limitam a capacidade de adquirir suprimentos de emergência e registrar novos produtos. Para estabilizar preços os sistemas de saúde terão que pagar mais, quando os orçamentos nacionais estão cada vez mais sobrecarregados. Realmente, esse dilema faz com que o preço dos medicamentos seja uma causa oculta da morte.
Leia o “blog do Ney Lopes” – informação e opinião
Jornal de Fato
OBRA / Ferrovia com 1.206 quilômetros ligará o sertão do Piauí, a partir da cidade de Eliseu Martins, ao porto de Pecém, no Ceará
Andrei A Verdélio Agência do BrasilOpresidente Luiz Inácio Lula da Silva visitou, nesta sexta-feira, 5, as obras da Ferrovia Transnordestina, em Iguatu, no Ceará. Ela está com 61% das obras concluídas. Ao discursar, Lula se comprometeu a trabalhar pela conclusão do empreendimento, iniciado em seu primeiro mandato, em 2006, e destacou a sua importância na geração de empregos e barateamento do custo do frete.
“Se depender do governo [federal], a gente vai terminar [a obra], porque o governo vai cumprir todos os acordos firmados e não vai permitir que faltem os recursos necessários para que a gente possa terminar essa ferrovia”, disse, citando os desafios técnicos e políticos que apareceram no desenrolar das obras.
“Essa ferrovia é importante não só porque ela gera empregos, não só porque ela barateia o transporte, não só porque ela facilita a vida de dois estados e de milhões de pessoas. Ela é importante porque o Brasil se transformou num país rodoviário e um país para ser mais produtivo, um país para ser mais leal ao seu povo, ele não pode abandonar a ferrovia para fazer rodovia, não.

P residente diz que trabalha pela conclusão da ferrovia
Ele tem que ter rodovia de qualidade, tem que ter ferrovia de qualidade, tem que ter hidrovia de qualidade, porque nós precisamos ter um sistema intermodal de transporte para utilizar todo o potencial para transportar gente, cargas e para baratear as coisas para o nosso povo”, acrescentou o presidente.
Pre V isão
A empresa privada Transnordestina Logística S/A (TLSA), do Grupo CSN, é a responsável pela construção e operação da
ferrovia e prevê que ela seja entregue até o primeiro trimestre de 2027.
A Ferrovia Transnordestina - com 1.206 quilômetros - ligará o sertão do Piauí, a partir da cidade de Eliseu Martins, ao porto de Pecém, no Ceará, passando por 53 cidades. O empreendimento é estratégico para o transporte de grãos, minérios, fertilizantes e combustíveis e deverá atuar com três terminais de carga no Ceará.
A infraestrutura logística atenderá, entre outros, o escoamento de grãos da
Primeira fase da Infovia Potiguar será inaugurada segunda-feira
A governadora Fátima Bezerra e o ministro das Comunicações, Juscelino Filho, inauguram nesta segunda-feira, 8, em Natal, a 1ª fase da Infovia Potiguar. O projeto vai levar internet para escolas públicas da rede básica de ensino, instituições de ensino superior federais e estaduais, hospitais de ensino e
órgãos públicos do interior do Rio Grande do Norte.
A 1ª fase da Infovia Potiguar vai viabilizar o acesso às cidades de CearáMirim, João Câmara, Mossoró, Pau dos Ferros e São Gonçalo do Amarante.
Ainda em Natal, após esta primeira agenda, o ministro Juscelino Filho participa da entrega de
computadores à Escola Municipal Carlos Bello Moreno, no Bairro Neópolis, e da Blitz da Telefonia Móvel em Natal, no bairro Areia Preta.
Confir A AgendA: - Inauguração da 1ª Fase da Infovia Potiguar
Data: 8/4/2024
Horário: 9h
região do Matopiba, formada pelo estado do Tocantins e partes do Maranhão, Piauí e Bahia, reduzindo o custo e dando mais competitividade à produção brasileira no mercado externo.
A Transnordestina é um dos projetos prioritários do Novo Programa de Aceleração do Crescimento (PAC) e recebeu, em 2023, investimento de R$ 269 milhões. O empreendimento gera 3,8 mil empregos diretos e indiretos, sendo mais de 90% de mão de obra local.
Local: Escola do Governo Cardeal Dom Eugênio de Araújo Sales - Centro Administrativo do Estado, s/nLagoa Nova – Natal/RN
- Doação de computadores
Horário: 10h30
Local: Escola Municipal Prof. Carlos Bello Moreno - Rua Arapiraca s/n - Conjunto Jiqui - Bairro Neópolis – Natal/RN
- Blitz da Telefonia Móvel
Horário: 12h
Local: Em frente ao letreiro da cidade de NatalAreia Preta - Natal/RN


CRISPINIANO NETO crispinianoneto@gmail.com
Nem Lázaro nem Carandiru.
Vitória da inteligência e estratégia
Os fugitivos da Penitenciária de Mossoró estão “de volta ao lar paterno”. Ou seja, nas celas de onde não deveriam ter saído. Claro que vão encontrar diferenças. A casa está rearrumada. Claro que não existe mais “A mesma praça, o mesmo banco, as mesmas flores do mesmo jardim...”. Não vão mais encontrar barras de ferro que possam ser retiradas para arrombar as brechas de uma luminária absurdamente grandes para um presídio, ainda que fosse de segurança mínima, câmeras de vídeo agora estarão ligadas para monitorá-los e não se verá mais o absurdo negligentemente criminoso de mais de um mês sem revistas às celas. E, claro, não vão encontrar alicate capaz de cortar uma tela de ferro em um canteiro de obras, por um descuido inexplicável de quem toma conta dos serviços. Caso tenham montado algum esquema de facilitação, o que até hoje não foi provado, não mais encontrarão diretor nem funcionários comprometidos com a bandalheira.
Parece que Lewandowski, com muito sal na moleira, varreu dos presídios federais de segurança toda a negligência da Era Bolsonaro, quando, ao contrário do que se dizia, “bandido bom era bandido solto”. A Bancada da Bala, em sua histeria histriônica, queria levar o ministro às barras da inquisição, ficou agora, sem justificativa e sem argumentos se conseguir levá-lo à tábua do matadouro. Ainda teve mais a prisão dos mandantes do assassinato de Marielle Franco, que pôs atrás das grades até o chefe geral da investigação, desnudando uma cadeia produtiva do crime que vai de mecânico que desmancha carros de criminosos até generais que comandaram a segurança pública no temerário governo Temer.
Tatu e Martelo estão presos, sem que a polícia tenha dado um tiro para matá-los, mesmo tendo havido todo um clima de confronto. E sem ameaçar os moradores da região, sem pirotecnia, sem fake, sem heroísmo de araque, ou seja, sem bravatas e sem carnificina. As polícias federais no Governo Lula têm, inegavelmente, outro nível. Na primeira metade do ano passado, Flávio Dino já exibia números pujantes no combate ao crime organizado. Apreensão de armas e drogas já era o dobro de 2022. Segundo o então ministro da Justiça, em 2022, a PF aprendeu 2.031 armas; nos primeiros meses de Lula, foram 3.965. Flávio Dino afirmou, à época, que as apreensões mostravam a “eficácia” da Polícia Federal no governo Lula. Como se sabe, o crime organizado lava muito dinheiro em escritórios de contabilidade, de advocacia, empresas de táxis, empresas de serviços em geral, lojas de fachada, escritório imobiliário, imóveis "alugados" e até em igrejas, naquilo que Gilmar Mendes chamou de narcomilícias evangélicas.
As críticas aos gastos com a operação são absolutamente ridículas. Imaginemos o grau de críticas se o governo não tivesse investido na caça aos bandidos. O tempo de captura não difere da média internacional em grandes fugas. A grande fuga de Alcatraz já está com mais de 60 anos e nanica de nada, nem com o poder da Cia e do FBI. Papillon viveu e morreu depois de décadas depois da fuga histórica. Balela dizer que tem presídio inviolável.
O ministro Lewandowski disse que a Força Nacional foi deslocada não para procurar os bandidos, mas para proteger a população do ambiente por onde eles poderiam estar passando. Muito mais gastos fez Bolsonaro com pães e queijos nas suas motociatas financiadas com o cartão corporativo. Os homens estão presos sem que tenha necessitado da espetacularização do foi feito no Caso Lázaro que acabou morto, porque o cadáver era um troféu para a polícia de um governador nazistóide. Assim foi também com os 111 presos do Carandiru e agora quase cem nas operações que o governo Tarcísio de Freitas está encetando em São Paulo, criando um caldo de cultura capaz de gerar a primeira milícia paulista.
Continuamos achando que houve negligência na gestão do presídio. Nada até agora nos estimula a pensar que não houve facilitação, “a troco não sei de quê”. Mas tudo isso é motivo para novas investigações. Que se foque na segurança dos presídios com absoluta imobilização dos bandidos e a segurança dos cidadãos que merecem estar fora deles.
GOIANA X GOIâNIA
enquanto Lula era ovacionado em Goiana, Pernambuco, na inauguração de uma fábrica de medicamentos contra hemofilia, e na inauguração de uma estação elevatória de água, Jair Messias bolsonaro, “o mito das multidões” era vaiado estrepitosamente em um restaurante de Goiânia, Goiás, sob estrepitosos gritos de “ladrão”. É... Mas é Lula que não pode sair nas ruas. “Presidente sem povo”. Pois, sim.
NAzISIONISmO
“Israel é o novo estado nazista”, dizem os judeus ortodoxos de Nova Yorque.
LuLA SOLTO; mORO PRESO
segundo o dIeese, a Lava-Jato fez o brasil perder R$ 172 bilhões em investimentos e desempregou 4,4 milhões de brasileiros. ‘serjo’ Moro e dallagnol são muito mais que ladrões de galinhas, como foram “qualificados” pelo ministro Gilmar Mendes. eles roubaram nosso futuro. anos depois, Lula está tentando recuperar os prejuízos, depois que ele foi considerado juiz parcial, porque colocou Lula atrás das grades, sem provas, por 580 dias. Lula está solto e ele pode ser preso a qualquer hora.Todo castigo pra Moro é pouco...
10,3% após pandemia
pesquisa / Setor cresce acima da média no segundo ano da covid-19

podiam ser mais adiadas e o próprio consumo de medicamentos”, acrescentou.
Oconsumo de bens e serviços de saúde foi impactado pela pandemia de covid-19 em seu primeiro ano (2020), ocorrendo o mesmo com os demais segmentos de bens e serviços que tiveram queda de 4,4% em volume.
Em 2021, no entanto, o volume do setor de saúde avançou 10,3%, quase cinco vezes mais do que os bens e serviços não relacionados à saúde (2,3%).
Os dados são da pesquisa Conta-Satélite de Saúde 2021, divulgada nesta sexta-feira (5), no Rio de Janeiro, pelo Instituto Brasileiro de Geografia e Estatística (IBGE).
Segundo Tassia Holguin, pesquisadora do IBGE, apesar do aumento dos procedimentos de emergência provocados pela pandemia, o isolamento social acabou reduzindo a busca por atendimentos não emergenciais em 2020.
“Em 2020, por conta do isolamento, a gente teve uma queda no número de procedimentos ambulatoriais e hospitalares. As pessoas deixaram de fazer cirurgias eletivas e de ir ao médico e ao dentista. Elas foram postergando”, explica Tassia. “Em 2021, elas precisaram retomar as consultas, cirurgias que não
EXPA n SÃO
Apesar da redução total do consumo de bens e serviços de saúde, em 2020 o setor teve um aumento de 1,9% nos postos de trabalho nesse primeiro ano de pandemia, enquanto o restante da economia acusou uma perda de 7%.
Os postos de trabalho da saúde pública cresceram 7%, enquanto a fabricação de produtos farmacêuticos teve alta de 4,9%. A saúde privada cresceu apenas 0,2%.
No ano seguinte, o emprego na saúde aumentou mais: 5,1%. No entanto, esse crescimento foi puxado pela saúde privada com alta de 10,8% nos postos de trabalho, enquanto a saúde pública caiu 2,5%.
As atividades relacionadas à saúde eram responsáveis por 8,4 milhões das ocupações no Brasil em 2021, ou 8% do total, bem acima dos 5,2 milhões (5,3%) de 2010.
As remunerações do setor de saúde totalizaram R$ 372,3 bilhões em 2021, o equivalente a 10,5% do total da economia em 2021.
As despesas com saúde no Brasil chegaram a R$ 872,7 bilhões em 2021, o equivalente a 9,7% do Produto Interno Bruto (PIB), que é a soma de todos os bens e serviços produzidos
cesar@defato.com

Avitória do professor doutor Rodrigo Codes na consulta à Reitoria da Ufersa não traz surpresa. Já era esperada. Ele foi o vitorioso de 2020, mas não assumiu o cargo porque o então presidente Jair Bolsonaro (PL) nomeou a terceira colocada da lista tríplice, atual reitora Ludimilla Oliveira. Havia o desejo da comunidade acadêmica, em sua maioria, de restabelecer o processo democrático, visto que agora é uma certeza que o presidente Lula (PT) nomeará o primeiro da lista, o eleito por professores, estudantes e técnicos administrativos. Outro ponto importante é que Ludimilla não teve capacidade para pacificar a Ufersa. Faltou a ela a articulação política-universitária capaz de serenar os ânimos. A reitora optou pelo caminho do confronto, pisou o tatame da direita x esquerda, e acabou não conseguindo viabilizar o projeto de reeleição. Fica a lição. Agora, é esperar que o futuro reitor tenha melhor sorte, ou competência, de construir uma única Ufersa e que seja de todos. Boa sorte.
Estamos prontos para transformar a Universidade
no país. Do total do PIB, 4% representavam os gastos do governo e 5,7% as despesas das famílias.
Comparando-se a participação da saúde pública no PIB, em relação a alguns países da Organização para a Cooperação e Desenvolvimento Econômico (OCDE), o Brasil ficou à frente do México (3,1%), mas atrás da média da OCDE (7,4%), Colômbia (7,1%), Chile (5,9%), Reino Unido (10,3%), França (10,4%) e Alemanha (11,1%).
Na comparação com 2020, houve uma queda da participação dos gastos do governo com saúde no PIB, já que no primeiro ano da pandemia, a saúde pública respondia por 4,2% da economia brasileira.
Em 2021, a despesa per capita com o consumo de bens e serviços de saúde de famílias e instituições sem fins de lucro a serviço das famílias alcançou R$ 2.387,50, enquanto os gastos per capita do governo com o fornecimento de serviços de saúde pública e medicamentos foram de R$ 1.703,60.
Em relação aos gastos das famílias com saúde, a maior parte (63,7% ou R$ 318,1 bilhões) foi com serviços de saúde privados. Os medicamentos responderam por 33,7% (R$ 168,3 bilhões) dos gastos com saúde.

O PSB do RN foi entregue à ex-vereadora Larissa Rosado com aval do PT da governadora Fátima Bezerra. O processo passou pelo gabinete da governadora. Daí, a certeza que o PSB apoiará o projeto do PT nas eleições municipais deste ano, em todos os municípios potiguares. Sem exceção.
1
com as ideias e propostas”
RODRIGO CODES
Professor doutor, primeiro colocado na consulta acadêmica à Reitoria da Ufersa
O prefeito Allyson Bezerra (União) está levando a nominata, que seria do PSB, para o Rede ou vai distribuir entre PSD e Solidariedade. Decisão será confirmada hoje, último dia do prazo de filiação. São mais de 20 précandidatos que aguardam a orientação do chefe do Palácio da Resistência.
A ex-prefeita Fafá Rosado se submeteu a procedimento cirúrgico para retirada de um cisto no rim direito. A cirurgia no Hospital São Lucas, em Natal, foi um sucesso. Em alta.
2
Até o fechamento desta edição, o ex-deputado Betinho Rosado seguia entubado na UTI do Hospital Wilson Rosado. Ele deu entrada na quinta-feira, 4, com quadro de AVC isquêmico, e foi diagnosticada infecção generalizada.
3
Depois de 20 meses, o tomógrafo enviado pelo Ministério da Saúde vai sair do caixote. Como previsto, o prefeito Allyson Bezerra retardou quase 2 anos para explorar em ano eleitoral.
4
A cervejaria Cabocla sedia hoje a quinta edição da Feira de Vinil de Mossoró. Vai reunir vendedores e colecionadores de discos de vinil e antiguidades em geral, a partir das 16h.
Sem a nominata palaciana, o PSB de Mossoró fica esvaziado para disputar vaga à Câmara Municipal. E não há tempo para reconstruir a chapa proporcional. Daí, Larissa Rosado está praticamente inviabilizada para tentar voltar à Câmara. Porém, ela tem a alternativa da disputa majoritária.
Larissa Rosado já disputou a Prefeitura de Mossoró quatro vezes. Em 2004 e 2008, perdeu para Fafá Rosado; 2012, foi derrotada por Cláudia Regina; e 2014, nas eleições suplementares, foi superada por Silveira Júnior.
FATOS EM FOCO
Estaremos hoje no batepapo sobre política e outros temas com o radialista Rodrigo Rodrigues, titular do programa “Fatos em Foco”, na webrádio Sal da Terra e transmitido pela Rede Universo de Comunicação. Confira, a partir das 20h.
Três ex-vereadores vão tentar voltar à Câmara de Mossoró pelo Progressistas: Nogueira de Dodoca, Arlene Souza e Cláudia Regina. Filiaram-se ao partido nesta sexta-feira, 5. Outros 20 précandidatos também foram filiados. O partido, que tem a ex-prefeita Rosalba Ciarlini, acabou surpreendendo no prazo final de filiação.
UFRN / Pesquisadores desenvolveram um novo processo para obtenção do carbeto de alta entropia
Wilson Galvão
Um grupo de cinco pesquisadores da Universidade Federal do Rio Grande do Norte (UFRN) desenvolveu um novo processo para obtenção do carbeto de alta entropia, formado com a combinação de elementos que apresentam boa resistência ao desgaste, alta dureza, elevada resistência térmica e alta resistência ao desgaste mecânico.
O invento, que possui a fórmula científica (TaVTiNbW)-C, foi objeto de pedido de depósito de patente no mês de março e contou com as contribuições de Anderson Costa Marques, Pâmala Samara Vieira, Thalita Queiroz e Silva, Meysam Mashhadikarimi e Uílame Umbelino Gomes, cientistas vinculados ao Programa de Pós-Graduação em Ciência e

Engenharia de Materiais (PPgCEM). Para entendermos melhor, os carbetos de alta entropia são materiais normalmente formados por cinco ou mais componentes, distribuídos homogeneamente para a formação do elemento.
Iraniano radicado no Brasil é dos pesquisadores envolvidos
Iraniano radicado no Brasil há mais de dez anos, o professor de Engenharia dos Materiais Meysam Mashhadikarimi é um dos pesquisadores envolvidos. Ele defende que o processo de patenteamento é relevante academicamente porque permite que as instituições de pesquisa e ensino possam proteger e comer -
cializar suas invenções. Mashhadikarimi conta com cinco depósitos de pedido de patente, dos quais dois já tiveram sua cartapatente expedida definitivamente (Três camadas, um material inédito e Medidas de nióbio, 90 partes de diamante).
Para ele, o processo de registro de patentes é um indicador do nível de ativi-
Tecnologia integra o portfólio da Vitrine Tecnológica da UFRN
A tecnologia também pode ser utilizada no campo de materiais de sistemas de proteção para ônibus espaciais e foguetes recicláveis; no campo avançado de energia nuclear; e nos campos extremos da indústria nacional, de defesa e militar. Agora, ela integra o portfólio da Vitrine Tecnológica da UFRN, conjunto de pedidos de patentes, concessões já reali-
zadas e programas de computador que receberam registro do INPI. A lista está disponível para acesso e consulta no site da Agência de Inovação (Agir), mesmo local em que os interessados obtêm informações a respeito do processo de licenciamento.
Dentro da Universidade, a Agência é a unidade responsável pela proteção e gestão dos ativos de pro-
Particularmente ao que foi desenvolvido na patente, a nova tecnologia está inserida na área de processamento de materiais via metalurgia do pó. A especificidade propicia uma ampla gama de aplicações, o que a credencia como uma alter-
dade científica e tecnológica de um país ou região, tendo assim um papel crucial na academia, uma vez que incentiva a inovação, promove a colaboração, contribui para o avanço do conhecimento e facilita a transferência de tecnologia para o mercado. O professor do Departamento de Engenharia de Materiais relata ainda que todos os inventores desse dispositivo, seja alunos ou professor, estão com suas pesquisas relacionadas à área de desenvolvimento
priedade intelectual, como patentes e programas de computador. As notificações de invenção, passo inicial de todo o processo, são feitas por meio do Sigaa, na aba pesquisa.
Diretor da Agir, Jefferson Ferreira de Oliveira, identifica que o apoio oferecido pela Agência aos alunos, docentes e pesquisadores abrange orientações sobre o que não pode ser patenteado, de acordo com a lei 9.279/96. Além disso, há o serviço de análise sobre pesquisa, o qual identifica estudos que não podem ser patenteados, mas podem ser licenciados via categoria
nativa promissora aos materiais convencionais.
“Este material pode ter suas aplicações em ambientes na indústria aeroespacial, que requerem uma boa resistência à corrosão e desgaste à alta temperatura, como para produzir tubulações,
em questão.
“Trabalhamos com ligas, carbetos de alta entropia e compósitos, analisando as possibilidades de cada vez mais, incentivar o desenvolvimento científico, tecnológico e industrial, com materiais de alta entropia. O material do carbeto de alta entropia especificamente está agora na análise de sinterização para avaliar sua densidade e melhores propriedades que podem ser obtidas com essa etapa”, elenca.
de Know-how, conceito que abrange uma reunião de experiências, conhecimentos e habilidades voltadas à produção de um produto ou artefato.
“O know-how pode ser transformado em um segredo industrial, mas envolto em um contexto jurídico. O ideal é buscar a assinatura do acordo, ou o contrato de confidencialidade, para garantir a exclusividade no uso desse conhecimento, justamente para que não seja repassado para outras pessoas, principalmente sem o conhecimento da empresa”, salienta Jefferson de Oliveira.
equipamentos químicos e baterias, por exemplo. Não bastasse, o carbeto de alta entropia possui características de alta resistência mecânica, excelente estabilidade em altas temperaturas e baixa condutividade térmica. Tudo isso o transforma em um material de revestimento de barreira térmica ideal, que pode ser usado em equipamentos de energia, como motores de turbina e turbinas a gás, e também tem espaço para aplicação no campo de energia”, destaca Anderson Marques.
O inventor acrescenta
que, por terem boa biocompatibilidade e bioinercia, os carbetos de alta entropia podem ser usados na área biomédica para produzir materiais como ossos artificiais, articulações artificiais e implantes. Ele defende que com o dispositivo criado na UFRN, é possível gerar melhor desempenho nas áreas de aplicação citadas e contribuir com a disseminação das pesquisas nesses campos da indústria, incentivando cada vez mais a pesquisa científica e tecnológica, sobretudo no âmbito regional.
Aviso de Desligamento Programado para Ampliações e Melhorias na Rede Elétrica
Para realizar serviços de manutenção e melhorias na rede elétrica, será necessário interromper, temporariamente, o fornecimento de energia na(s) seguinte(s) área(s):
13/04/2024 (Sábado)
Das 07h30 às 12h30
Município: Assu. Bairro: Janduis. Rua José Dantas Pessoa e Adjacências. (136 Clientes)
15/04/2024 (Segunda-Feira)
Das 08h às 11h30
Município: Apodi. Bairro: Liberdade. Rua Deputado Dalton Cunha e Adjacências. (179 Clientes)
Das 08h30 às 13h30
Município: Assu. Bairro: Vertentes. Travessa José Tavares Junior e Adjacências. (240 Clientes)
Das 14h às 17h
Município: Tabuleiro Grande. Bairro: Centro. Rua Joaquim Pereira e Adjacências. (23 Clientes)
16/04/2024 (Terça-Feira)
Das 08h às 12h
Município: Água Nova. Bairro: Centro. Rua Nossa Senhora de Fátima e Adjacências. (132 Clientes)
Município: Riacho de Santana. Localidade: Sítio Quintas e Adjacências. (Clientes)
Das 08h às 13h
Município: Apodi. Localidade: Povoado Soledade e Adjacências. (100 Clientes) Município: Almino Afonso. Localidade: Sítio Deserto e Adjacências. (18 Clientes)
Importante: Sem prévio aviso, essas programações podem sofrer atrasos ou ser canceladas por impedimentos técnicos. Caso os trabalhos sejam concluídos antes do horário previsto, a rede será energizada sem qualquer outra comunicação.
Aponte a câmera do seu celular para QR Code acompanhe a programação e saiba mais sobre Desligamento Programado. www.neoenergia.com
Telmir de Souza
Soare S
Dr. em Filosofia, professor do Departamento de Filosofia da UERN
Há uma frase muito pungente que assevera que “nenhum pai deveria enterrar o próprio filho”. Um evento devastador como esse seria algo contra a natureza, uma vez que os pais, por mais que perdurassem, deveriam, segundo a ordem das coisas no nosso mundo imaginário, falecer antes dos filhos, cabendo a estes enterrá-los. Segundo esse pressuposto, os filhos nascem, desenvolvem-se, crescem e com eles crescem e amadurecem os pais. É um movimento de tempo simultâneo, de tal forma que os filhos, quando velhos, estariam maduros para cuidar dos pais e vê-los, finalmente, descansarem.
De hoje em diante, depois da morte de nosso caríssimo amigo Philipe Villeneuve, consideramos que essa frase deveria ser adaptada para outras situações e condições que não sejam a de pai ou de mãe, exclusivamente. Certamente não há que se pensar na igualdade entre dores tão profundas, se bem que a dor de cada pessoa é a dor de cada pessoa, incomensurável. Entretanto, estamos nos referindo a outras pessoas e outras profissões que comportam tais dores em função de determinadas perdas. Estamos falan -

do daquelas pessoas e daquelas profissões que professam de forma irremediável uma paixão da alma, a paixão de lidar com os filhos que são de outros, tomando-os como se fossem nossos, num processo de acompanhamento, crescimento e, finalmente, descanso semelhante aos dos pais. No nosso caso, falamos na condição de professor, assim, “nenhum professor deveria ‘enterrar’ um aluno”.
Professores existem em função de seus alunos. Em seus alunos os professores encontram a razão de ser deles, de seus sonhos e desejos. Existem alunos nos
quais os professores se reencontram em suas próprias histórias em um tempo perene: no tempo do passado, quando tudo é luta para terminar um curso como assim o fizeram; no tempo presente, nas lutas travadas para se constituir profissionalmente, dar significado ao curso recém-terminado e na busca por encontrar um espaço no mercado de trabalho e, por fim, no futuro, quando os projetos do discente começam a dar frutos e, finalmente, eles ultrapassam o docente, demonstrando a atualização das suas potências, realizando toda a admiração que o
Diocese de Mossoró perdeu o seu mais jovem sacerdote
Padre Philipe era o mais jovem sacerdote da Diocese de Santa Luzia de Mossoró. Tinha apenas 27 anos quando o seu coração parou de bater na noite desta terça-feira, 2. Uma perda que abalou a comunidade católica de Mossoró e de toda a região Oeste do Rio Grande do Norte, dada a empatia e a boa convivência do jovem religioso com toda a sociedade.
O jovem Philipe Villeneuve Oliveira Rego foi ordenado sacerdote da Igreja Católica em 4 de agosto de 2023, no Dia do Padre, por dom Mariano Manzana (hoje bispo Emérito). A solenidade ocorreu no adro da Matriz de Nossa Senhora da Conceição, na cidade de Pau dos Ferros, a sua terra natal.
Apesar de jovem, padre Philipe ocupou fun -
ções importantes na Diocese de Santa Luzia em sua breve vida religiosa. Ele era o vice-reitor do Seminário Santa Teresinha, diretor Pedagógico do Colégio Diocesano Santa Luzia (CDSL) e diretor da FM 105 Santa Clara.
Essa última função ele ocupou para suceder o padre Sátiro Cavalcanti Dantas, falecido em 27 de novembro de 2023.
professor devotava ao discente. Philipe Villeneuve estava traçando esse percurso, em meio ao qual surgiu, na relação docente e discente, uma aprofunda amizade e uma genuína admiração por tudo que ele viria a realizar.
Philipe nos mostrava a genuína alegria em cada encontro, expressa num sorriso emoldurado pelo aparelho dentário. O abraço apertado, indicando tanto a proximidade da amizade quanto o distanciamento gerado por uma saudade imediata, por não termos tido nesses tempos tempo para estarmos mais próximos como gostaría -
mos. Toda despedida era o prenúncio de uma saudade e da vontade de que o próximo encontro se desse o mais breve possível. Mas eis que Philipe se foi...
Pensando sob uma ótica diferente, a da presença e a do agradecimento, foi infinitamente bom ter conhecido alguém tão especial. Infelizmente, a causa mortis principal da condição humana é a vida. Estar vivo é a condição de possibilidade da morte. Não há morte sem vida, nem vida sem morte. Essa é a mais dura de todas as realidades que nos cercam. Enterrar um filho, enterrar um aluno só acontecem porque algo se deu anteriormente, uma presença que se expressa muito mais pela existência do que pela ausência.
Ter nutrido sonhos e esperanças de curto e longo prazo junto a Philipe Villeneuve e, principalmente, sobre a vida dele fazem todo o sentido dado o sentido da nossa profunda relação de afeto nascida pelo amor à filosofia. Muitas dessas esperanças e projetos se realizaram até o dia de hoje e todas foram muito preciosas. Philipe se formou em Licenciatura em Filosofia e me deu a alegria de estar na sua banca de Conclusão de Curso.
Ele também se tornou Padre e assumiu, mediante toda sua competência e esmero, muitas responsabilidades que somente ele poderia realizar a contento de uma forma tão especial. Assim, mesmo as lágrimas que nos sobrevêm, nada teria sido se Villeneuve não
tivesse acontecido. Foram muitos anos de relacionamento fraterno e acadêmico. Talvez, na nossa escala de tempo, tenham sido poucos esses anos. Mas o que é o tempo, de fato? Esse tempo breve sob a terra foi infinito em termos de profundidade, anos que nos fazem, hoje, sermos um pouco mais felizes por essa terna saudade que agora habita em nós.
Na última vez que vimos Philipe, tivemos a oportunidade de andar juntos meio quarteirão. Na verdade, eu o acompanhei porque ele tinha pressa. Era noite. Aparentava cansaço e indicava que tinha ainda algumas coisas a tratar. Andei com ele sabendo que meu destino estava na direção oposta, mas eu queria saber novidades. Despedimo-nos e voltei ao ponto em que tínhamos nos encontrado. Desejei no meu coração toda a felicidade do mundo para ele. Sua partida em definitivo, a despeito de tudo que compartilhamos, deixou-nos um pouco mais solitários nesse mundo tão vasto. Perdemos um aluno, perdi um amigo, perdemos o compartilhar de novos sonhos, perdemos alguém que era, para nós, alguém de casa. Se há algo que nos consola nesse momento inconsolável é saber que agora, finalmente, Philipe vai poder descansar. Vimos isso no último sorriso que imaginamos ter visto na face dele, enquanto todos se despediam, na Catedral de Santa Luzia, e isso nos deixou saudosamente consolados.
Em 10 de março passado, padre Philipe publicou texto em sua conta no Instagram, com reflexão sobre o amor. Leia:
“Tenho refletido muito sobre o amor, não como sentimento, mas sim compromisso com as pessoas, com a vida, com o vínculo de humanidade que temos.
E me preocupo que, no Cristianismo, o amor, mandamento primário e essencial, passe a ser barganha de salvação. Sim, alguns
fazem qualquer gesto amoroso pensando naquilo que receberão em troca.
As relações são utilitaristas: usamos os outros para aquilo que queremos obter e ainda buscamos impressionar Deus, achando, nós, que Ele irá ver o externo, não o coração.
Amar não deveria ser moeda de troca, mas sim uma pulsão de vida, uma naturalidade do coração. Amamos porque é bom amar, nos faz bem, faz-nos
mais humanos, sentimonos mais na essência do que somos.
“Padre, devemos amar para alcançar o céu”. A eternidade não precisa de amor interesseiro, para lá vão os que amaram com gratuidade de coração.
Jesus nos mandou amar como Ele amou. Ora, Ele não morreu para ganhar algo. Sua entrega é um gesto de amor gratuito e desprendido.
E basta.”











O certame será realizado em quatro cidades potiguares
OMinistério da Gestão e da Inovação em Serviços Públicos (MGI) divulgou levantamento do total de inscrições para o Concurso Público Nacional Unificado (CPNU), modelo inovador de seleção de servidores públicos criado pelo órgão federal. Em Mossoró, o número de inscritos passou de 7 mil.
De acordo com o balanço, Mossoró registra 7.414 inscrições para o certame.
Em todo o Rio Grande do Norte, o número de pessoas inscritas para o CPNU chega a 42.967. Natal é a cidade com mais inscritos.
A capital potiguar soma 28.447. Outros dois municípios potiguares também receberão as provas. Par -
namirim tem 4.302 inscritos e Caicó o total de 2.804 inscrições realizadas.
As provas serão realizadas no próximo dia 5 de maio, em 228 cidades do país. Com 2,1 milhões de inscritos, o CPNU já é o concurso com o maior número de candidatos realizado no Brasil, superando os recordes anteriores, dos certames do Banco do Brasil de 2021 e 2022, que registraram, respectivamente, 1,6 e 1,5 milhão de inscritos.
Os candidatos inscritos no Concurso Público Nacional Unificado disputarão as 6.640 vagas oferecidas no maior processo seletivo para o serviço público da história do país. O Ministério da Gestão e da Inovação informou
que enviou ofícios aos governadores e prefeitos dos municípios onde serão aplicadas as provas. O documento solicita cooperação para garantir a segurança e a logística necessárias à realização do certame. A correspondência, assinada pela ministra da Gestão, Esther Dweck, destaca a importância de evitar a realização de grandes eventos nas cidades onde o Concurso Público Nacional Unificado (CPNU) será realizado, a fim de facilitar o deslocamento dos candidatos e garantir a segurança nos locais de prova.
Além disso, a Fundação Cesgranrio, empresa aplicadora do concurso, em parceria com órgãos como a Secretaria de Segurança
Pública do Ministério da Justiça e o Instituto Nacional de Estudos e Pesquisas Educacionais está em contato com as autoridades estaduais e municipais para tratar de questões logísticas e de segurança.
Também para viabilizar a logística e a segurança do certame, uma rede de aplicação foi estabelecida conectando órgãos das administrações públicas federais e estaduais. Houve, inclusive, a integração com a Secretaria Nacional de Segurança Pública (Senasp/MJSP), Polícia Federal (PF), Polícia Rodoviária Federal (PRF), Agência Brasileira de Inteligência (Abin), Força Nacional (FN) e Secretarias de Segurança Pública Estaduais.
Con C urso Públi Co n aC ional / Em todo o RN, são mais de 42 mil inscrições efetuadas para o concurso unificado
Horários de abertura e fechamento dos portões
Para garantir o bom andamento do certame, o Ministério da Gestão e da Inovação em Serviços Públicos (MGI), em parceria com a Cesgranrio, divulgou os horários de abertura e fechamento dos portões, bem como de início e duração das provas. Os candidatos devem se atentar aos horários para evitar atrasos e imprevistos. O CPNU será aplicado simultaneamente em 228 cidades do país. Pela manhã, segundo o MGI, os portões serão abertos às 7h30 (horário de Brasília).
Nesse turno, os inscritos para os blocos de nível superior (1 a 7), responderão 20 questões objetivas - de múltipla escolha - sobre conhecimentos gerais
e uma questão dissertativa de conhecimento específico. Para o bloco de nível médio (bloco 8), os candidatos farão 20 questões objetivas - de múltipla escolha - e uma redação. Já no período vespertino, os portões abrirão às 13h (horário de Brasília). À tarde, os candidatos dos blocos de nível superior (1 a 7), responderão a 50 questões objetivas - de múltipla escolha - de conhecimentos específicos. Enquanto os inscritos no bloco de nível médio farão mais 40 questões objetivas - de múltipla escolha. As provas para o nível médio não incluem questões dissertativas, apenas a redação no período matutino.
> Apagam velinhas hoje: Isabeline Oliveira, Renan Freire, Felipe Pinheiro, Clézimo Lima de Azevedo, Leovigildo Cavalcante Neto, Talita Maia, Marina Elali, Carlos de Medeiros Luz. Felicidades!!!
> Aniversariam amanhã, 7: Mércia Mesquita Silva, Creudo Neto, Marta Escóssia Morais, Marcos Medeiros, Dulce Valdes de Andrade, José Dias, Gilseleno Jales Amorim, Edgard César Burlamaqui de Lima, Antônia Gomes de Oliveira, Mariana Soares de Lima, Antônia Maria de Medeiros, Kalyano Riketh Medeiros, Francisco Valdomiro de Morais. Parabéns!!!
> Hoje finalizo a primeira semana de abril desejando os cinco "S": saúde, sabedoria, serenidade, sucesso e sexo!”
> O gastrólogo Alexandre Néo, primo querido, fazendo o maior sucesso com a sua Prático Gastronomia. Seus temperos são excelentes!
> Padre Charles Lamartine é fã de Santo Agostinho que diz: “a medida certa de amar é amar sem medidas”
> Uma das coisas boas que a rede Globo conseguiu produzir nos últimos meses foi o remake de Renascer. É sempre assim.
> Andar sobre as águas ou afundar. Andar de cabeça erguida, confiante. Acreditando. Deixe que digam, que pensem, que falem...
> A estilista number one do Rio Grande do Norte, Fátima Carlos, vestiu a Doutora Julita Senna para o Baile de Formatura no Curso de Psicologia da Faculdade Católica do Rio Grande do Norte.
> A decisão pela mudança exige que façamos escolhas. Quando perceber um hábito negativo em ação, escolha fazer diferente. Insista no processo. A prática leva ao êxito.
> Enquanto seu lobo soprava lá fora, a caravana passava bem na cara dos caretas. Fim.



Que sei eu do que serei, eu que não sei o que sou?
Ser o que penso?
Mas penso ser tanta coisa!
E há tantos que pensam ser a mesma coisa que não pode haver tantos!
Gênio? Neste momento
a Mestra em
Um livro na mão e um sorriso no rosto. A leitura tem que nos conquistar. Euzinha e a Mestra em Educação Rafaella Costa nos preparativos para a nossa quarta coletânea com as histórias inspiradoras dos médicos na obra: Para todo mal, a cura!

Pro finde semana começar feliz, o cabeleireiro Fefê entre as luluzinhas elegantes no Villa Grega, o point dos bacanas, Fátima Carlos, Janete Queiroz e Socorro Carlos. Salve, salve!

A amizade é uma dádiva. E eles sabem disso muito bem pelos momentos desfrutados juntos. Quem? A empresária Marluce Bezerra com Zoraide e Georgiano Azevedo. No clique, almoçando na melhor barraca de praia de Canoa Quebrada, a Chega Mais Beach do amigo Luiz Nogueira. Show!


Cem mil cérebros se concebem em sonho gênios como eu, E a história não marcará, quem sabe?, nem um, Nem haverá senão estrume de tantas conquistas futuras.
Não, não creio em mim.
Em todos os manicômios há doidos malucos com tantas certezas!
Fernando Pessoa
Marinaldo Rocha assinou a beleza da debutante linda de 2024, Giovana Rosado. No Vintage também ficaram mais lindas e deslumbrantes a mãe Roberta e a avó Betinha Rosado. Quem sabe, sabe!

A nutricionista Jarda Jacinta, mãe muito amada de Eloá e Helena Belmont, serena e confiante. DNA de belezas raras. Gosto de gostar.








I ustrativa
As provas do concurso público da Educação serão realizadas neste domingo (7). O certame é promovido pela Prefeitura de Mossoró e oferecerá 112 vagas imediatas em cargos de níveis médio e superior do quadro de pessoal da Secretaria Municipal de Educação (SME). O último concurso na área foi realizado há 10 anos.
A aplicação das provas ocorrerá pela manhã (para o cargo de nível médio) e à tarde (cargos de nível superior). A remuneração inicial varia de R$ 1.527,88 a R$ 5.338,87. O concurso oferece, além das vagas imediatas, cadastro de reserva com 560 oportunidades.
As vagas estão distribuídas para os cargos de professor da Educação Infantil e Anos Iniciais e Anos Finais do Ensino Fundamental (Língua Portuguesa, Mate-

O certame oferecerá 112 vagas imediatas em cargos de níveis médio e superior
mática, Ciências, História, Geografia, Língua Inglesa, Ensino da Arte, Ensino Religioso e Educação Física). Também há oportunidades para supervisor escolar e nutricionista.
Pela primeira vez na história da Educação municipal, um concurso público também oferece vagas para
professor de Atendimento Educacional Especializado (AEE), psicólogo educacional, assistente social e profissional de apoio à Educação Inclusiva.
O concurso compreenderá as seguintes etapas: provas objetivas e discursivas, de caráter eliminatório e classificatório; pro-
va de títulos de caráter classificatório, para os cargos de nível superior; avaliação biopsicossocial aplicada aos candidatos inscritos na condição de Pessoa com Deficiência (PcD) e procedimento de heteroidentificação para candidatos que se autodeclararem negros.



ESTADO DO RIO GRANDE DO NORTE MUNICÍPIO DE CORONEL JOÃO PESSOA
AVISO DE CHAMAMENTO PÚBLICO Nº 001/2024
O Município de Coronel João Pessoa/RN, através da Secretaria Municipal de Educação, Cultura, Esporte, Lazer e Turismo, torna público para ciência dos interessados, que realizará a credenciamento para a aquisição de produtos alimentícios da agricultura familiar para a alimentação escolar de alunos da rede municipal de Coronel João Pessoa/RN, conforme termo de referência.
Período de recebimento: até 24 de abril de 2024 às 10h00mim. LOCAL DE ENTREGA DE DOCUMENTOS: Exclusivamente pelo site https://www. portaldecompraspublicas.com.br
Maiores informações pelo licitacao@coroneljoaopessoa.rn.gov.br
Coronel João Pessoa/RN, 05 de abril de 2024.
Ângela Kelly Simão de Souza Lima Secretária
UNIMED MOSSORÓ –COOPERATIVA DE TRABALHOS MÉDICOS
CNPJ/MF 08.566.440/0001-12
ASSEMBLEIA GERAL EXTRAORDINÁRIA (AGE)
EDITAL DE CONVOCAÇÃO
O Presidente do Conselho de Administração da UNIMED MOSSORÓ – Cooperativa de Trabalhos Médicos, no uso de suas atribuições estatutárias, convoca os Senhores (as) Médicos (as) Cooperados (as), que nesta data somam 144 (cento e quarenta e quatro), para se reunirem em Assembleia Geral Extraordinária (AGE), de acordo com o Artigo 30, do Estatuto Social da Cooperativa de Trabalhos Médicos, que se realizará no dia 25 de abril de 2024, na Sede da UNIMED MOSSORÓ, situada a Av. Rio Branco, 984 – Centro, 1º Andar – sala 19, Mossoró - RN, 59600-145, às 15h00 horas em primeira convocação, com a presença de dois terços dos cooperados em condições de votar; às 16h00 horas em segunda convocação, com a presença de metade mais um dos cooperados em condições de votar e, em terceira e última convocação, às 17h00 horas, com a presença de no mínimo 10 (dez) cooperados em condições de votar, para deliberarem a seguinte ordem do dia: ORDEM DO DIA
01. Deliberação sobre a Venda do Terreno da Unimed Mossoró, situado na Rua Manoel Cristino de Morais, nº 67, Bairro Nova Betânia, CEP 59.611-380, Mossoró/RN.
02. Outros assuntos de interesse geral da Cooperativa. O número de Cooperados para efeito de “quórum” apto ao voto é de 120. Mossoró/RN, 04 de abril de 2024.
HAROLDO AMARAL
Desempenho / Resultado é melhor que na última avaliação, que teve nota de IGC de 3,007 e agora subiu para 3,196.
Com conceito 4, no Índice Geral de Cursos Avaliados da Instituição (IGC), referente a 2022, a Universidade do Estado do Rio Grande do Norte (Uern) se manteve entre as melhores universidades do país. O valor máximo é 5. Os dados do IGC foram divulgados na última semana pelo Instituto Nacional de Estudos e Pesquisas Educacionais Anísio Teixeira (Inep).
O resultado é ainda melhor que na última avaliação. Em 2018, a Uern registrou a nota de IGC Contínuo de 3,007 e agora subiu para 3,196.
Além do IGC, o Inep divulgou os outros dois itens que fazem parte dos Indicadores de Qualidade da Educação Superior. São eles: o Indicador de Diferença entre os Desempenhos Observado e Esperado (IDD) e o Conceito Preliminar de Curso (CPC).
Entre as Instituições de Ensino Superior (IES) do Brasil, apenas 25% possuem IGC 4. Vale destacar que entre as 15 Universidades estaduais do Nordeste, a Uern ocupa a 6ª posição. E entre as 101 IES Públicas estaduais, a Uern está na 23ª posição.
Para a reitora Cicília
Maia, os resultados dos índices refletem a dedicação, o trabalho e o compromisso de todos que fazem a Universidade. “Estamos aqui pra agradecer todo o esforço coletivo. Desde 2017, que isso é fruto de um trabalho de gestão, fruto de um trabalho de cada um e cada uma que faz a Universidade do Estado do Rio Grande do Norte. Motivo de celebrar e dizer que o ano de 2024 começa com todo o gás e com toda a nossa vontade, disponibilidade e amor, que é do tamanho dos nossos sonhos”, agradeceu.
O professor Wendson Medeiros, titular da Asses-
soria de Avaliação Institucional (AAI) e presidente da Comissão Própria de Avaliação (CPA), classificou o resultado do IGC como extremamente positivo.
“A Uern conseguiu alcançar, na edição passada, o IGC 4 e seria um grande desafio manter esse IGC. Mantivemos o IGC 4 em função de termos aumentado a nota no IGC contínuo. Isso é uma grande conquista para a nossa instituição. É um resultado que demonstra o crescimento e a evolução do trabalho realizado pela Uern”, comentou.
O docente agradeceu a toda comunidade acadêmi-
ca envolvida. “Aos chefes de departamento pelo comprometimento com os resultados do Enade, aos programas de pós-graduação pelo comprometimento com os resultados, à gestão da professora Cicília Maia e do professor Chico Dantas, que tem a avaliação institucional como uma prioridade”, diz o professor.
Ele destaca que o trabalho desenvolvido dentro da AAI com a CPA tem esse intuito de se autoconhecer cada vez mais, buscando aprimorar os processos para conseguir resultados de excelência como esse do IGC.
A professora Fernanda Abreu, titular da Pró-Reitoria de Ensino de Graduação (Proeg), entende que o resultado é decorrência de um trabalho coletivo muito significativo, que envolve toda a comunidade acadêmica, à qual agradecemos por todo o esforço que vem sendo desempenhado para construir uma Uern cada vez melhor.
“Isso nos aponta ainda para um caminho de continuidade, onde é importante mantermos os fins e as ações comuns em prol de cada um dos nossos cursos tão relevantes para a transformação social”, avalia.

Uern conquista conceito 4 no IGC
Professores e diretores comemoram resultados dos cursos avaliados
No IDD, foram considerados os cursos de Administração, Ciências Econômicas, Ciências Contábeis, Serviço Social, Direito, Jornalismo, Publicidade e Propaganda e Turismo, do Campus Mossoró; Ciências Econômicas e Administração, do Campus Pau dos Ferros; Ciências Contábeis, do Campus Patu; Ciências Econômicas, Campus Assú; e Turismo e Direito, Campus Natal.
Comparando com 2018, a maioria dos cursos subiu de 3 para 4, alguns mantiveram o 4, enquanto apenas três desceram um ponto. No CPC, os mesmos cursos citados anteriormente, em sua maioria, se manteve na faixa 4. Para o diretor da Faculdade de Ciências Econômicas (Facem), Leovigildo Cavalcante, esse resultado diz respeito a uma série de ações coletivas desen-
volvidas pelos departamentos na atuação em projetos de pesquisa, extensão e ensino, buscando uma maior relação teoria/ prática, inclusive com reformulações dos projetos políticos pedagógicos se adequando às novas realidades e ao mercado. “É uma conquista de muitos esforços ao longo dos anos que aflora nos resultados pelos cursos da Facem obtidos”, destaca.
O diretor da Uern Pau dos Ferros, Agassiel Alves, destaca que os resultados são reflexos da dedicação e empenho dos servidores em garantir uma educação de qualidade à sociedade do Alto Oeste Potiguar e de todas as regiões do Estado. “Muito nos orgulha estes resultados”, frisa.
A vice-diretora da Uern Assú, Guianezza Mescherichia, reforça que o resultado do ICG da UERN reflete, sobretudo, o compromisso da comunidade acadêmica na promoção de uma educação de qualidade. “Nós, que fazemos
a Uern estamos sempre empenhados na busca de resultados expressivos e que reforçam, socialmente, a importância da nossa instituição”, declara.
O IDD busca mensurar o valor agregado pelo curso, ao considerar os resultados dos estudantes no Exame Nacional de Desempenho dos Estudantes (Enade), ao fim da graduação, e o desempenho, no Exame Nacional do Ensino Médio (Enem), dos ingressantes na educação superior.
Por sua vez, o CPC combina diferentes aspectos, como desempenho dos estudantes; valor agregado pelo curso; corpo docente; e condições oferecidas para o desenvolvimento do processo formativo.
O IGC é resultado da avaliação das instituições de educação superior e corresponde à média das notas do CPC (cursos de graduação) e dos conceitos CAPES dos cursos de programas referentes às pós-graduações stricto sensu, ponderadas pelo número de matrículas de cada curso.
OGoverno Federal gastou R$ 6 milhões ao longo dos 51 dias de buscas aos dois presos que fugiram do presídio federal em Mossoró. A informação foi publicada nesta sexta-feira (5) pelo jornal Folha de São Paulo, que deu conta de que a caçada custou, em média, R$ 121 mil por dia.
A reportagem detalhou que, com base em dados fornecidos pelo Ministério da Justiça, a Polícia Rodoviária Federal (PRF) gastou R$ 3,3 milhões; a Força Nacional, R$ 1,4 mi; e a Força Penal Nacional, R$ 625 mil, totalizando pouco mais de R$ 6 milhões. “Os valores incluem despesas com passagens, diárias, combustível, manutenção e operações aéreas.
A matéria lembrou que a operação envolveu centenas de policiais, drones, helicópteros e cães farejadores. Foram 51 dias de buscas aos criminosos Rogério da Silva Mendonça,
Presos de Mossoró /
Informação foi publicada nesta sexta-feira (5) pelo veículo com sede em São Paulo, que deu conta de que a caçada custou, em média, R$ 121 mil por dia
Fotos Cedida


Portal diz que bandidos do RJ montaram escolta e rota de fuga para fugitivos de Mossoró
Traficantes do Morro do Alemão, no Rio de Janeiro (RJ), traçaram a rota de fuga de Rogério Mendonça e Deibson Cabral e forneceram abrigo, alimento, transporte, escolta e dinheiro aos fugitivos da Penitenciária Federal de Mossoró. Essa
informação foi publicada na manhã desta sextafeira (5), pelo site de notícias Metrópoles. Segundo a coluna “Na Mira”, do portal sediado no Distrito Federal, os dois presos, recapturados na tarde da última quintafeira (4), no estado do Pa-
rá, após 51 dias de buscas, “chegaram até a receber um Pix de um criminoso da capital fluminense, no valor de R$ 5 mil, nos primeiros dias de fuga”. O site reportou também que “Investigações apontam que bandidos do Norte e do Nordeste estavam ins -
Plano dos presos de Mossoró seria chegar à Bolívia
O plano dos dois presos que conseguiram fugir do presídio federal em Mossoró no dia 14 de fevereiro deste ano seria chegar à Bolívia. Pelo menos é o que foi amplamente divulgado pela imprensa nacional nesta sexta-feira (5). Até o fechamento desta matéria, na tarde de ontem, ainda não havia qualquer informação oficial sobre isso e nem mais divulgações de outras informações do ministério da Justiça sobre o assun -
to. Em entrevista coletiva na última quinta, o ministro da Justiça, Ricardo Lewandowski, disse que os presos realmente queriam sair do Brasil e pretendiam ir para o exterior, mas, na ocasião, ele não detalhou qual seria o des -


truídos a oferecer todo o apoio necessário a Rogério e Deibson”.
Ainda conforme o portal, no âmbito das investigações sobre a fuga, a facção criminosa carioca Comando Vermelho (CV) quis passar uma mensagem aos integrantes do grupo, sobretudo aos então fugitivos. “Ao fornecer apoio logístico, escolta, armas e dinheiro, os líderes destacaram que ‘quem está com eles não será abandonado’”, pontuou a coluna. E a coluna
tino planejado. No entanto, diversos veículos da imprensa nacional noticiaram ontem que a pretensão dos dois presos de Mossoró era chegar à Bolívia, como publicou o site da CNN Brasil, atribuindo a informação a “fontes ligadas à investigação”. O portal pontuou que o país da América do Sul faz fronteira com o Acre, justa -
“Paulo Cappelli”, também do site Metrópoles, publicou na manhã de ontem que a Polícia Federal acredita que os presos recapturados “não entregarão os comparsas do CV (Comando Vermelho)” e que “não vão colaborar com o interrogatório planejado pelo Ministério da Justiça”. O portal destacou que “sem previsão de redução da pena, Nascimento e Mendonça não teriam estímulo suficiente para entregar os cúmplices”.
mente a área de atuação original dos dois presos ligados à filial do Comando Vermelho no estado.
“Mas a suspeita principal dos investigadores não é de que a travessia seria pelo Acre, e sim, por Rondônia”, detalhou o site.
36, “Martelo”, e Deibson Cabral do Nascimento, 34, “Tatu”. Os dois fugiram da Penitenciária Federal de Mossoró em 14 de fevereiro, e foram recapturados na tarde da última quintafeira (4), em Marabá, no estado do Pará, a cerca de 1.600 quilômetros do local da fuga.
!Reportagem detalhou que PRF gastou R$ 3,3 milhões; Força Nacional, R$ 1,4 mi; e a Força Penal Nacional, R$ 625 mil
“Central telefôniCa” A rede criminosa montada pelo Comando Vermelho para dar suporte aos fugitivos de Mossoró forneceu chips e celulares a Rogério Mendonça e Deibson Cabral, como uma espécie de “minicentral telefônica”. A informação foi destaque ontem em notícia também do site Metrópoles, que reportou que a medida foi adotada “numa tentativa de dificultar o rastreamento feito pela Inteligência da Polícia Federal”.
Ontem, a PF disse que as investigações do órgão seguiriam para apurar as circunstâncias da fuga e identificar todos os envolvidos na rede de apoio. r e Cambiados
Na madrugada de ontem, os dois presos foram recambiados para o presídio federal em Mossoró, onde fugiram no dia 14 de fevereiro deste ano. Sob forte escolta policial, a dupla foi trazida do estado do Pará, onde foi recapturada nesta quinta, depois de 51 dias como foragidos.
PriMeiro triMestre / Estado divulgou ontem dados que mostram que uma redução de 7% em veículos roubados e aumento de 5% em veículos recuperados e devolvidos aos legítimos proprietários
Ototal de veículos roubados no Rio Grande do Norte está caindo e a quantidade de carros e motos recuperados pelas forças policiais está aumentando. É o que mostram, segundo material divulgado nesta sextafeira (5) pelo Governo do Estado, as estatísticas da segurança pública potiguar ao fim do primeiro trimestre deste ano.
De acordo com a Secretaria de Estado da Segurança Pública e da Defesa Social (SESED), dados consolidados pela Coordenadoria de Informações Estatísticas e Análises Criminais (COINE) mostram que a redução no total de veículos roubados ao longo dos primeiros três meses do ano, em comparação com o primeiro trimestre de 2023, foi de 7%.
Já a quantidade de veículos recuperados e devolvidos aos seus legítimos proprietários cresceu 5%, ainda conforme os dados divulgados ontem pelo Governo do RN. Segundo o Estado, em números absolutos, nos primeiros três

Estado afirma ter recuperado 123 veículos no primeiro trimestre de 2023 e 129 neste ano
meses de 2023, foram roubados em território potiguar 724 veículos. Já no mesmo período de 2024, foram 673 crimes da mesma natureza.
Ainda de acordo com o balanço disponibilizado nesta sexta pela Sesed/RN, quanto aos veículos recupe -
Cúpula da Segurança Pública do Rio Grande do Norte debate sobre procedimentos policiais eletrônicos
Estatística, planejamento estratégico e procedimentos policiais eletrônicos foram alguns dos principais pontos debati-
dos pela Polícia Civil do Rio Grande do Norte na manhã desta sexta-feira (5), em uma reunião no auditório da Delegacia
Crianças violentadas I
Policiais civis da delegacia especializada em atendimento à Mulher de Macau (deaM/Macau) concluíram, nesta sexta-feira (5), as investigações de crimes de estupro de vulnerável e de ameaça contra duas crianças, no município de Macau/RN. Na ocasião, as duas crianças, hoje adolescentes, teriam sido abusadas sexualmente pelo investigado, de 31 anos, que era conhecido da família.
rados e devolvidos, foram 123 casos registrados no primeiro trimestre de 2023; contra 129 no mesmo período de 2024. Para o Executivo potiguar, esses números refletem o trabalho integrado das forças de segurança pública no combate à criminalidade.
Geral da Polícia Civil, em Natal. O encontro reuniu o secretário da Segurança Pública, coronel Araújo, a delegada-geral, Ana Cláudia Saraiva, o delegadogeral adjunto, Herlânio Cruz, e diretores e delegados regionais.
No encontro, cada delegado regional contou sobre as experiências positivas
!Governo potiguar diz ter registrado 724 veículos roubados nos primeiros três meses de 2023, contra 673 crimes da mesma natureza no mesmo período deste ano
das respectivas unidades com o uso do Sinesp - Procedimentos Policiais Eletrônicos (PPE), que permite aos profissionais da Polícia Civil de realizarem o registro de ocorrências policiais de forma integrada, bem como a gestão dos procedimentos dentro do sistema, possibilitando ainda aos operadores da segurança
pública o acesso a diversas bases de dados.
O sistema disponibiliza ainda para a instituição o despacho homologatório dos Boletins de Ocorrência (BO) e a lavratura dos demais procedimentos, além da gestão cartorária e compartilhamento e uso de dados e informações registrados pelos entes federados
Sistema prisional do RN recebe 20 novos policiai penais
O sistema prisional do Rio Grande do Norte ganhou um novo reforço no efetivo. Nesta sexta-feira (5), o secretário da Administração Penitenciária (SEAP/RN), Helton Edi, empossou durante a manhã 20 vinte novos policiais penais. A Seap/RN informou que os profissionais irão atuar nas principais unidades carcerárias do estado.
A secretaria destacou que a Polícia Penal está com o efetivo previsto em Lei completo com 1.444 servidores. “Vocês chegam num momento de crescimento da Polícia Penal. Confiamos e temos muitas expectativas em todos”, disse Helton Edi, durante a solenidade que contou com a presença de autoridades, como a secretária adjunta Arméli Brennand; o diretor da Academia da Polícia Penal, Marcelo Rocha; a coordenadora executiva da Administração Penitenciária, Regina Ribeiro; dentre outros.
“A Polícia Penal forte é imprescindível na segurança pública. A paz nas ruas depende da paz nas cadeias”, ressaltou a secretária adjunta. Esse grupo de novos policiais penais já tinha sido nomeado no mês passado, totalizando 265 novos policiais penais.
participantes no âmbito das três forças (Polícia Civil, Polícia Militar e Corpo de Bombeiros). A Polícia Civil do RN conta com 11 delegacias regionais, sendo elas em São Paulo do Potengi, Mossoró, Caicó, Patu, Nova Cruz, Santa Cruz, Alexandria, Goianinha, Pau dos Ferros, Macau, João Câmara e Goianinha.
Crianças violentadas II o fato aconteceu no ano de 2020. ao longo da investigação, diversas diligências foram realizadas. Inclusive, as vítimas foram periciadas e submetidas a avaliações psicológicas por peritos do Instituto Técnico-Científico de Perícia (ITeP), que comprovaram os danos. atualmente, o investigado está recolhido na Cadeia Pública de Parnamirim, estando à disposição da Justiça.
estelionato, falsidade documental, associação criminosa e lavagem de dinheiro são delitos imputados a uma mulher, que teve pedido de concessão de habeas corpus julgado e negado pela Câmara Criminal do TJRN. o órgão julgador manteve entendimento presente na sentença de primeira instância. o caso foi divulgado ontem pelo TJRN.
o TJRN informou que os envolvidos criaram uma falsa agência de modelos e aplicavam golpe ao oferecer vagas em produções e, de acordo com a Polícia Civil, algumas vítimas perderam de R$ 200 a R$ 1,5 mil cada em um dos estados onde o grupo agiu. as vítimas registraram boletim de ocorrência por crime de estelionato e contaram que a quadrilha anunciava pelo Instagram uma seletiva para modelos, sem exigir experiência prévia na profissão.
fabiowillard@hotmail.com

fabio willard de oliveira



Como mandante ou visitante, todos os jogos serão longe de casa
ODPotiguar precisa planejar onde mandará seus jogos da Série D. Sem Nogueirão e com dúvidas sobre público no Edgarzão, as dificuldades aumentam. Levar jogos para Natal seria uma saída, mas sabendo que não terá público sequer para cobrir despesas. A alternativa mais viável para o alvirrubro neste momento é fechar parceria com alguma prefeitura para ter, ao menos, as despesas cobertas, como transporte, hospedagem, alimentação e taxas do uso do eventual estádio. Entendendo que nenhum estádio em um raio de 80 quilômetros possui laudos para sediar jogos oficiais, partir para outro estado seria uma saída. De outra forma, o Seridó, com o Bezerrão, em Currais Novos, ou mesmo o 9 de Janeiro, em Pau dos Ferros. A escolha será pela forma menos dolorosa, pois não há como fugir da necessidade de pegar a estrada, seja como mandante ou como visitante.
epois de uma campanha altamente positiva, em seu retorno à primeira divisão, o Baraúnas esbarrou no tribunal e perdeu inicialmente sua vaga nas semifinais do segundo turno, fase que começa hoje. O possível uso irregular do jogador Ramon, que teria atuado com três cartões amarelos acumulados, seria o pecado. A diretoria promete recorrer, indo até à última instância, no caso o STJD. Lá, reúne chances de recuperar o espaço perdido. Já nas barras do TJD, onde precisa primeiro recorrer à segunda turma, historicamente, as chances são quase nulas. De acordo com especialistas que ouvi, o regulamento é dúbio, dando margem para as duas teses (pró e contra). Ocorre que a doutrina jurídica que diz que, na dúvida, pró-réu, não foi seguida na prática. Os auditores locais não tiveram dúvidas, tanto que a votação foi por unanimidade contra o tricolor. Bem, tudo pode acontecer, inclusive nada. Mas a tomarmos pelo histórico, uma reversão no STJD não é nada de outro mundo. Lá, normalmente, a análise é fria e segue a cartilha, não pesando nada além da lei. É nessa possibilidade onde reside a esperança dos tricolores.

Time da Rádio Tapuyo, no extinto campo do Hotel Thermas . Na imagem, alguns colegas que deixaram saudades: Daniel, (não identificado), Mister Freitas (in memoriam), Olismar Lima (in memoriam), Elias Pereira e não identificado; Luiz Neto (in memoriam), Raimundo Paraíba, Silveira Neto e Dantas Júnior.
Friburguense, na década de 1990, no campo da R e FFSA, em Mossoró: Panchico, Almeida Café, Isaac, Neguinho, Diassis, Ivanílson, Toinho, Jocelito, Bento e Betinho (falecido); Novo, Civan (falecido), Roosevelt, Vivi, Tutula, e veraldo, Fabio Oliveira, Raério Cabeça e Paulo Brequim.
Professor, já resolvi o problema. Coloquei o ônibus dentro da garrafa do café”
Ele teve um problema no “Calcanhar de Aquino”
Mickey, massagista do Potiguar, antes de um jogo pela Série D em 2017, em Teresina-PI. Mostrou habilidade, pois colocar apenas a garrafa dentro do ônibus é para os fracos.
Chico, massagista, na época do Baraúnas, explicando uma contusão do meia Da Silva.
Sem público
E o Edgarzão não tem laudo da PM. O fato não impede jogos, no entanto, enquanto não tiver esse documento, os jogos acontecerão de portões fechados, como o de hoje, entre Potiguar e Globo.
Explicado
Tendo afirmado o direito ser bom a seu favor, resta saber se o Baraúnas manterá a ação em harmonia com o discurso, sobre recorrer até o STJD, caso seja preciso. Além da classificação, é sobre a credibilidade junto à torcida, imagem que chegou a ser arranhada no episódio da inversão do mando de campo contra o América.
Quem visitou o Edgarzão esta semana informa que há várias partes com aviso de interdição, como o setor de cadeiras e um trecho das arquibancadas. A não liberação da PM para público acaba não sendo por acaso.
Boa ideia
Vamos lembrar que em 2006, ano da conquista do Baraúnas, o TJD potiguar, em julgamento do caso “Sílvio Madona”, aplicou 6 a 0 contra o Assu, em reclamação do ABC. No STJD foi totalmente inverso.
Anulados
Na impossibilidade de público no Edgarzão, levar o jogo contra o Santa Cruz para Pau dos Ferros, como se cogita no Baraúnas, é possibilidade interessante, pois pode gerar engajamento do público Pauferrense, saudoso de jogos oficiais.
Também em 2006, com a reversão da situação no STJD, as primeiras finais disputadas pela dupla Potiba foram anuladas e os jogos remarcados. Uma repetição dos fatos, agora, não está descartada.
Retrospecto
Mais um
O histórico é amplamente favorável ao Baraúnas, no confronto com o Potyguar. Em 17 jogos oficiais, são sete vitórias do time mossoroense, contra três do adversário, além de 32 gols marcados e 22 sofridos. Mas isso é para efeito de história e não é garantia de êxito no presente.
Outro caso de possibilidade de irregularidade surgiu nas últimas horas. O Globo teria utilizado um atleta não profissional, de 20 anos, o que fere a legislação. e m se confirmando, o Globo trocará de lugar com o Potyguar Seridoense, atual rebaixado.
Retrospecto II
Maria Preá
Nesta sextafeira (15), o exatacante Euller, também conhecido como “O filho do vento”, completou 53 anos. Euller fez história pelo São Paulo, Palmeiras, Atlético Mineiro e Vasco da Gama.
Neste domingo (7), o bairro Doze Anos, berço do Baraúnas, amanhece em festa. O ex-lateral do tricolor, no ano de 1985, Marcondes Maia “Tchê”, completa 60 anos de idade. ele é irmão do expresidente do clube, Marcos Maia. Figura do bem. Parabéns, amigo!


Quanto a Potiguar e Globo, há uma ligeira vantagem do time de Ceará-Mirim. Em 20 jogos, foram seis vitórias do Potiguar, contra oito do Globo. Em gols, foram 18 do Príncipe, contra 26 da Águia.
Kalhinho Melo
WELLINGTON LOPES
Bairro Boa Vista
Alto de São Manoel
Torcedor do Ceará
Torcedor do Potiguar

Nesse caso, não tem tribunal que mude. O Potiguar sabe bem disso. e m 2019, perdeu por unanimidade no STJD, pelo uso do jogador Sávio, amador com menos de 16 anos, o que também é proibido. Derrota por unanimidade em todas as instâncias.
Não é pra tanto
Desinformados
O Potiguar chegou a anunciar treino fechado, no Edgarzão, para enfrentar o Globo. Depois mudou o local do treino para a Ufersa, que não tem como fechar. Com o Globo no estado que está, fechar treino é fazer tempestade em copo d´água.
Disputas
Não é de hoje que está claro o desinteresse dos clubes do interior em analisarem os regulamentos do estadual. Não tiram dúvidas porque não as tem, exatamente por não lerem o documento. Apegam-se, apenas, à fórmula de disputa. Depois são pegos no contrapé.
Finais
Quem da dupla Potiba vencer neste fim de semana encerrará qualquer risco de rebaixamento. O resultado de ambos na rodada anterior, somado ao de seus concorrentes encaminhou o desfecho. Segue em aberta a luta pela vaga na Série D.
Acontecem hoje, no Ginásio Pedro Ciarlini, as finais do futsal, pelo Circuito esportivo Mossoroense. Às 17h, tem a final no masculino. e m seguida, 18h30, é a vez de Fênix e Ajax decidirem o título no feminino. A entrada é franca.


ESTADUAL / Atacante voltou forte e é arma do Potiguar para duelo da semifinal contra o América neste domingo
MARCOS SANTOS
Da Redação
OPotiguar conta com o bom momento do atacante Talisson para tentar chegar à final do 2º turno do Campeonato Estadual. O atleta se recuperou de lesão no joelho que o tirou de combate por dois meses, e vem cumprindo boas exibições nessa etapa do campeonato. O duelo da semifinal contra o América será neste domingo, 7, às 15h30, no Edgarzão, em Assú.
Contratado ao futebol carioca desde o início da pré-temporada, Talisson vive “good vibes” reveladas em números e rendimento, tendo marcado dois gols e dado uma assistência para gol em quatro jogos, após
sua volta aos gramados.
“Fico feliz por estar nesse bom momento, ajudando o Potiguar com gols e assistências, e contando com todo o apoio dos meus companheiros também, que estão me ajudando muito nessa fase positiva. E vou ficar ainda mais feliz se conseguirmos atingir nosso objetivo no Estadual”, disse ele, que agradece por estar vivendo esse bom momento na carreira.
“Essas oportunidades são cruciais para minha carreira e devo aproveitá-las ao máximo. No início da temporada, me machuquei e fiquei um período em recuperação. O grupo (atletas), comissão técnica, diretoria e minha família me deram forças e hoje estou aqui representando o Potiguar com gols importan-

tes”, completou. Antes da lesão, o atleta participou de dois jogos do Potiguar na Pré-fase da Co-
pa do Nordeste. Na decisão nos pênaltis contra o Sampaio Corrêa/MA, Talisson bateu e converteu a última

Amsantos@defato.com

lguns torcedores, nas redes sociais, perguntaram-nos sobre a questão judicial travada pelo Baraúnas, a conduta da Federação em marcar os jogos, e o que isso pode acarretar lá na frente.
Primeiro, provavelmente, o campeonato não irá parar, porque o Pleno do TJD, geralmente, mantém o entendimento da primeira comissão disciplinar da casa – que julgou o “Caso Ramon” e deu provimento ao protesto do ABC contra o Baraúnas – e assim tende a indeferir o pedido de liminar do tricolor mossoroense.
A Federação, por sua vez, só paralisa mediante decisão judicial e está na responsabilidade dela em marcar os jogos. Pelo cronograma, a Federação fará a semifinal do 2º turno neste fim de semana, planeja marcar a decisão do returno para quarta, 10, e possivelmente a decisão geral do campeonato para o domingo seguinte, 14, e quarta, 17 (isso se o América não der o liso, vencendo os dois turnos).
Nos bastidores, o Baraúnas sabe que dificilmente irá reverter a decisão judicial em âmbito estadual, mas sabe que precisa atender ao ritual, sem atropelar a ordem cronológica dos recursos.
Em esgotando os recursos no RN, o tricolor buscará a paralisação do campeonato no Superior Tribunal, no Rio de Janeiro, conforme sua diretoria já antecipou. A apreciação da liminar pode levar dias, com a competição rolando ou até mesmo já terminando, e não se sabe também se o resultado será favorável para parar, ou determinar apenas para a Federação não homologar o campeão, diante do processo em trâmite.
A essa altura, dos supostos acontecimentos, pode-se dizer que o campeonato correria o risco de acontecer o que aconteceu em 2006, com alguns jogos retrocedidos, em caso de o Baraúnas obter sucesso no julgamento do STJD. Assim, o que se pode dizer é que Potiguar x América, neste domingo, é imexível; podem atuar sem serem atingidos por decisão do “tapetão”. Já o restante dos jogos, em sua reta final, pode ser cancelado.
Santa x ABC
Se não houver surpresa via tribunal e a tendência é essa, Santa Cruz e ABC jogam neste sábado, 6, no Barrettão, em Ceará-Mirim, decidindo vaga à final do 2º turno do Estadual. O momento do tricolor é melhor, enquanto o alvinegro, que “ressuscitou” no campeonato, busca se refazer, após resultados ruins e críticas veementes do presidente Bira Marques.
Potiguar x América
Na outra semifinal entre Potiguar x América, há uma tendência para equilíbrio, com base no que as equipes apresen-
taram no meio de semana no embate direto, na Arena das Dunas. Agora, o jogo será em campo apertado, no Edgarzão, em Assú, o que sugere ainda mais um aparelhamento de forças. A bola rola às 15h30.
Potyguar ou Globo, o rebaixado?
Além do “Caso Ramon”, outro está por vir, e atende aos interesses do Potyguar Seridoense e que pode rebaixar o Globo FC. No campo, o Potyguar caiu, mas o tapetão poderá salvá-lo. O time descobriu suposta infração do time de Ceará-Mirim.
cobrança, que levou a equipe para a segunda-fase da Pré, e no jogo seguinte, contra o Botafogo Paraibano, ele marcou de cabeça o gol de empate no tempo normal de partida – nos pênaltis, o time mossoroense foi eliminado para o Belo. Esses dois jogos foram realizados fora de casa.
Contra o América, Talisson é presença certa com-
pondo a linha de frente, junto com Sampaio e Wilson. O atleta comentou sobre o que espera da partida deste domingo, com base no que viu do América, quando as duas equipes se enfrentaram no meio de semana, pela última rodada da fase de grupos, na Arena das Dunas.
“Sabemos que o jogo contra o América será muito difícil. Conhecemos bem o adversário, tivemos uma partida muito difícil na Arena das Dunas. Agora vamos jogar no Edgarzão, com o apoio da nossa torcida, e isso é muito importante para continuarmos somando grandes resultados”, disse o jogador, que foi autor do gol no empate com o América por 1x1.
O duelo entre os alvirrubros será em jogo único e, em caso de empate no tempo normal de partida, o classificado será decidido nas cobranças de tiros livres na marca do pênalti. O zagueiro Douglas Santos, que foi poupado no último jogo, reforçará o time mossoroense nessa semifinal.

Saúde e bem-eStar / A reeducação alimentar é uma ferramenta importante para quem deseja melhorar a saúde, mudar o estilo de vida, manter o peso ou emagrecer
Areeducação alimentar é uma mudança de hábitos e comportamentos perante a comida, em que a pessoa aprende a fazer escolhas de alimentos mais saudáveis e a manter as refeições em horários regulares, ajudando a prevenir o surgimento de doenças como diabetes, pressão alta e obesidade.
A reeducação alimentar é uma ferramenta importante para quem deseja melhorar a saúde, mudar o estilo de
Como fazer a reeducação alimentar
Algumas recomendações para fazer a reeducação alimentar são:
1.Beber de 1,5 a 3 litros de água por dia
Beber de 1,5 a 3 litros de água por dia é importante, porque esta bebida não contém calorias e ainda ajuda a manter o estômago cheio, diminuindo a sensação de fome e a vontade de comer.
Uma sugestão para quem tem dificuldade de beber água é colocar um pedacinho de gengibre ou espremer meio limão em uma garrafa de água e ir bebendo durante o dia. Outra possibilidade para aumentar a ingestão de água é beber chás sem açúcar, como chá verde, camomila, cidreira ou hibisco.
2.Mastigar bem e devagar os alimentos
Mastigar bem e devagar os alimentos aumenta o tempo de duração das refeições, ajudando o cérebro a entender que o estômago está cheio, indicando o momento certo que se deve parar de comer, ajudando na manutenção de peso ou no emagrecimento.
Uma dica para mastigar bem os
vida, manter o peso cer, mantendo o peso ideal, sem “efeito sanfona”, pois estimula a escolha de alimentos mais saudá veis para o resto da vida.
É importante que a reeducação ali mentar seja orientada pelo nutricionis ta, que vai avaliar a saúde e as necessi dades nutricionais da pessoa, planejan do uma dieta individualizada para pro mover uma mudança gradual dos hábi tos alimentares.




alimentos é pousar os talheres no prato entre uma garfada e outra. Além disso, comer em local tranquilo e evitar distrações, como assistir televisão ou mexer no celular também melhora a atenção durante as refeições, ajudando a mastigar mais devagar.
3.Comer pelo menos 3 porções de frutas frescas por dia
As frutas frescas, como maçã, laranja, pera, morango e banana, são ricas em fibras, que ajudam a prolongar a saciedade e diminuir a vontade de comer ao longo do dia, favorecendo o emagrecimento.
Além disso, comer 3 porções de frutas frescas por dia, ajuda a diminuir a vontade de comer doces, diminuindo a quantidade de açúcar e calorias da dieta, e prevenindo situações como obesidade e diabetes, por exemplo.
4.Priorizar a ingestão de cereais integrais
Os cereais integrais, como arroz integral, pão integral e macarrão integral, são ricos em fibras que ajudam a controlar a fome ao longo do dia, reduzindo a quantidade de ingestão de alimentos e favorecendo a reeducação alimentar.
Além disso, as fibras presentes nos cereais integrais também ajudam a diminuir a absorção de gordura dos alimentos, ajudando no emagrecimento saudável.
5.Comer a cada 3 ou 4 horas
Comer a cada 3 ou 4 horas, incluindo café da manhã, lanche da manhã,
almoço, lanche da tarde e jantar, por exemplo, ajuda a controlar a fome ao longo do dia, evitando que se coma grandes quantidades de comida nas próximas refeições.
Além disso, pessoas que sofrem de compulsão alimentar correm um risco maior de comer grandes quantidades de comida quando ficam muitas horas sem comer, optando muitas vezes por alimentos com muita gordura e açúcar.
6.Comer proteínas magras em todas as refeições Comer proteínas magras, como frango, tofu, queijo, ovos ou peixe em todas as refeições ao longo do dia, ajuda a diminuir a gordura e as calorias da dieta.
Além disso, as proteínas são digeridas lentamente e, por isso, são ótimas opções para ajudar no controle da fome e diminuir a vontade de comer entre as refeições, favorecendo a reeducação alimentar.
7.Incluir vegetais no almoço e no jantar Os vegetais, como alface, tomate, abóbora e chuchu, devem ser consumidos diariamente no almoço e no jantar, pois estes alimentos contêm ótimas quantidade de fibra e água, importantes para controlar a fome, ajudando a diminuir a quantidade de alimentos na dieta.
8.Evitar alimentos ultraprocessados Os alimentos ultraprocessados, como
refrigerante, sorvete, refeições do tipo fast food e molhos prontos, devem ser evitados, pois contêm muito açúcar e gordura, aumentando as calorias da dieta e dificultando a reeducação alimentar.
9.Planejar bem as compras e refeições Planejar e organizar bem as refeições ajuda a listar os alimentos que devem ser priorizados e os que devem ser evitados durante as compras, facilitando o controle da qualidade e quantidade de calorias da alimentação.
Além disso, planejar as compras e as refeições também ajuda no preparo de pratos simples, mas que sejam variados e saborosos, evitando a monotonia e estimulando o consumo de alimentos mais saudáveis.
10.Praticar atividades físicas regularmente
Praticar atividades físicas regularmente, de 3 a 5 vezes por semana e com duração de 30 a 60 minutos por dia, é fundamental, pois os exercícios físicos promovem a liberação de hormônios do prazer, como endorfina e dopamina, evitando a ansiedade e a compulsão alimentar. As atividades físicas também aceleram o metabolismo, favorecendo a queima do excesso de gordura corporal e ajudando na manutenção ou perda de peso.
Se deseja fazer uma reeducação alimentar, marque uma consulta com o nutricionista mais perto de você.
> Hoje é dia de vivas para Clézimo Lima Azevedo, Carlos de Medeiros Luz, o professor Leovigildo Cavalcante Neto (UERN), a cantora Marina Elali, Isabellini Mendes Oliveira, Antônio Beneventi e Jales Júnior. Amanhã (7), é dia de festa para Marcos Medeiros, Creudo Neto, Marta Escóssia Morais, o deputado José Dias, Gilseleno Jales Amorim, Edgard César Burlamaqui de Lima, Alexandra Rabelo, Anna Rita Moura e Fernanda Helena Soares. Para vocês paz, saúde, amor e alegrias. Parabéns!
As Feras
No programa As Feras deste domingo (7), eu e Saudade Azevedo vamos bater um papo com o empresário e exvereador Genivan Vale, précandidato a prefeito pelo PL, dentro do quadro “De cara com As Feras”. Temos ainda o Sacolão das Feras, sorteio de brindes e aquela seleção musical que todos aprovam. esperamos por vocês a partir das 19h na 93 FM/Nossa TV. Até lá!
Na segunda (1º), o colunista comemorou idade nova e durante todo o dia telefonemas, mensagens e mimos tornaram-no especial. Primeiro, os parabéns com a turma da Liga de Mossoró com bolo da Maricota Doce de Mariane Vale e delícias da Chamego Doce. Depois, um café dos melhores na Casa Grãos Café com Katharina Gurgel, Márcia Dutra e Chris. e à noite, no aniversário de Érica Anzilotti, mais um bolo da amiga Tereza Cristina Fernandes Teixeira. Por tudo e por tanto, muito obrigado! Um agradecimento bem especial faço aos amigos da imprensa de todo o estado que dedicaram generosos espaços em seus veículos para registrarem a data. Thanks!

O inimigo
Na quinta (28), eu e meus irmãos reunimos familiares e amigos queridos para comemorar os 80 anos de nossa mãe, Maria Denise dos santos Chaves no Renata Motta Gastronomia em Natal. Tarde/noite emocionante e cheia de significados. ela vestiu Fátima Carlos. Tereza Cristina Fernandes assinou o bolo, lindo, como tudo que ela faz. A Santti Doce de Thereza Raquel cuidou dos doces, deliciosos, diga-se. Socorro Paiva grifou os bem-vividos. Cardápio de Renata Motta e borbulhas da Casta Real de Guilherme Luz, com música de eduardo Teixeira. Tudo ao gosto da aniversariante!

Nós: Graco, Marcelo, Iang Júnior e o colunista com d. Denise.



Érica Anzilotti reuniu familiares e amigos queridos na segunda (1º), no Blu Point do Vila Grega, para comemorar idade nova com total apoio do maridão, o Chef Giullio Anzilotti. Noite com delícias Blu Point, drinks do top Fernando Henrique, bolo de Tereza Cristina Fernandes e a presença de muita gente querida. Show!

Giullio e Érica Anzilotti diante do belo bolo de Tereza Cristina Fernandes.

O encontro de Naide Bessa e Luana Medeiros (Luana com aniversário na sexta, 12).


A odontóloga Evela Maia Fernandes, folhinha


Padre Charles Lamartine e Karenine Fernandes.


A amiga


6).





























deSaFIO Para a Saúde / As bactérias resistentes sobrevivem e se multiplicam mesmo expostas a antibióticos; uma pesquisa recente utilizou inteligência artificial como mecanismo de direcionamento para o controle dessas superbactérias
As bactérias resistentes desenvolvem a capacidade de sobreviver e se multiplicar mesmo quando expostas a medicamentos antimicrobianos, como antibióticos. Igualmente conhecidas como superbactérias, apresentam uma resistência que é resultado de processos naturais de evolução e seleção, nos quais as bactérias mais suscetíveis são eliminadas, enquanto as resistentes sobrevivem e se reproduzem, transmitindo suas características para as gerações futuras.
O número de amostras de bactérias resistentes a antibióticos analisadas no Laboratório de Pesquisa em Infecção Hospitalar do Instituto Oswaldo Cruz aumentou de pouco mais de mil em 2019 para quase 2 mil em 2020 e ultrapassou 3,7 mil no período de janeiro a outubro de 2021, evidenciando um aumento na disseminação dessas superbactérias durante a pandemia de covid-19.
PODE SURGIR?
Alguns fatores favorecem o aparecimento de superbactérias, garantindo situações que geram a resistência bacteriana.
As bactérias podem acumular mutações em seus genes ao longo do tempo, inclusive capazes de conferir resistência a antibióticos.
As mutações genéticas podem ser transferidas horizontalmente, pois bactérias trocam material genético diretamente entre si, permitindo a transferência de genes de resistência de uma espécie para outra.
Uso indiscriminado de antibióticos
O uso inadequado de antibióticos em humanos, animais e agricultura pode acelerar o desenvolvimento de resistência, visto que
as bactérias são expostas constantemente aos medicamentos. O desafio no combate às bactérias resistentes está relacionado à diminuição das opções de tratamento eficaz.
À medida que mais bactérias se tornam resistentes, a medicina e a ciência enfrentam dificuldades para encontrar medicamentos que possam combater as infecções de forma eficaz. Isso pode levar a infecções mais graves, complicações de saúde prolongadas e até mesmo morte.
Além disso, a pesquisa e o desenvolvimento de novos antibióticos são caros e demorados, o que limita a disponibilidade de novas opções terapêuticas.
MEDIDAS PARA EVITAR A PROPAGAÇÃO DE RESISTÊNCIA MICROBIANA
Novas pesquisas indicam a importância de prevenir a infecção por bactérias multirresistentes, considerando a dificuldade de desenvolver novos antibióticos eficazes contra essas superbactérias. Algumas medidas preventivas são:
• Uso responsável de antibióticos: limitar o uso desnecessário de antibióticos em humanos e animais para reduzir a pressão seletiva que impulsiona o desenvolvimento da resistência;
• Higiene e prevenção: práticas de higiene rigorosas e medidas preventivas podem ajudar a reduzir a propagação de infecções bacterianas;
•Desenvolvimento de novos antibióticos: investir em pesquisa e desenvolvimento de novos medicamentos antimicrobianos para enfrentar as bactérias resistentes;
• Combinação de terapias: explorar o uso de combinações de diferentes antibióticos para superar a resistência.

INTELIGÊNCIA ARTIFICIAL COMO ALIADA NO COMBATE ÀS SUPERBACTÉRIAS
Uma abordagem no combate à resistência bacteriana é reutilizar medicamentos existentes com perfis de segurança conhecidos. Nesse sentido, um artigo publicado em 2022 apresenta uma abordagem de aprendizado de máquina chamada InterPred que visa identificar o mecanismo de ação de antibióticos usando métodos interpretativos.
Determinar o mecanismo de ação desses medicamentos continua sendo um desafio e consome muito tempo.
O estudo, publicado na revista Scientific Reports, periódico da Nature, indica que o InterPred identifica com sucesso características importantes e as relaciona com mecanismos de ação dos antibióticos, fornecendo informações



sobre possíveis candidatos a antibióticos com novos modos de ação.
A abordagem do InterPred contribui significativamente para o combate à resistência microbiana pela descoberta de:
1 – Novos mecanismos de ação, podendo levar ao desenvolvimento de tratamentos mais eficazes contra bactérias resistentes;
2 – Priorização de moléculas promissoras, pois permite a identificação de moléculas com compostos bioativos não documentados anteriormente que podem ter modos de ação únicos e desconhecidos, tornando-as candidatas promissoras para novos medicamentos.
3 – Otimização da utilização de recursos, considerando que os recursos para pesquisa e desenvolvi-
mento de novos antibióticos são limitados, sendo então crucial o foco em compostos com maior potencial de sucesso.
4 – prevenção da resistência futura, pois moléculas com mecanismos de ação inéditos têm menos probabilidade de encontrar patógenos já resistentes.
5 – Melhor compreensão dos mecanismos de ação, por entender quais partes das moléculas dos antibióticos interagem com os patógenos.
Essa abordagem tem o potencial de enriquecer a caixa de ferramentas terapêuticas contra infecções resistentes e, assim, ajudar a enfrentar esse desafio global de saúde.
Fonte:
FIOCRUZ. Detecção de bactérias resistentes a antibióticos triplicou na pandemia. 2021

georgianoazevedo@gmail.com
> Nossa equipe subiu a Serra da Tapuia para produzir mais uma campanha de moda para o Midway Mall e marcamos “território” na cidade de Sítio Novo. De lá, seguimos para “desbravar” a região, que é uma das mais lindas do nosso Estado.
E, claro, fomos ao famosíssimo Castelo de Zé dos Montes, que é o grande cartão-postal do município por sua beleza que contrasta com a região serrana.
Nossa equipe de moda teve George Azevedo na Direção e este colunista assinando o Styling, com os assistentes Weykon e Sandra Máximo. João Paulo Oliveira cuidou da beleza e tivemos no cast: Daliane Baptista, Larissa Sabino, Mairla Galdino, Natália Santana e Hugo Guimarães. Todos da Tráfego Models.
Levamos na bagagem as principais tendências da coleção outono-inverno, como o animal print, alfaiataria, xadrez, metalizadas, Tweed, tons terrosos, black jeans, militar, mix de texturas, risca de giz, cargo e a pegada oversized.
“Fizemos uma pesquisa nas lojas do shopping para captar as principais tendências da estação”, falou George.
Marcas como Riachuelo, C&A, Le Lis Blanc, Jorge Bischoff, A Graciosa, Morana, Dudalina, Toli, YouCom… participaram dessa campanha.
Direção de Moda: George Azevedo | Styling: Georgiano Azevedo | Assistentes de produção; Sandra Máximo e Weykon
Fotos: Humberto Lopes | Beleza: João Paulo Oliveira | Modelos: Daliane Baptista, Larissa Sabino, Mairla Galdino, Natália Santana e Hugo Guimarães. (Tráfego Models) |
Agradecimento: Prefeitura de Sítio Novo




QUARTA�FEIRA, 12 DEABRILDE2023



















e alguém fosse escrever uma história das artes plásticas no Estado do Rio Grande do Norte teria que obrigatoriamente dar o seu a seu dono, ou seja, outorgar o real valor ocupado por Maria do Santíssimo.” Essa afirmação é do professor, escritor e crítico literário Márcio de Lima Dantas.
Para o estudioso, em matéria de arte há de se buscar categorias que são da disciplina conhecida como Antropologia do Imaginário. Assim sendo, a pintora de São Vicente teria de ocupar o lugar que lhe compete, uma vez que uma honesta e não adulatória análise da sua profícua e bela obra sugere passar por categorias daquele domínio do conhecimento.
Desse modo, o professor Márcio lembra a importância dessa nossa artista visual: um resgate requintado, fiel e honesto de reconhecimento àquela que é o mito fundante, matriz e nutriz, de nossa tradição naïf: Maria do Santíssimo.
Boa leitura!
Ângela Karina

Balada do Impostor
Entrevista com Cristina Franco Presidente do Conselho da Associação Brasileira de Franquias – ABF.

Maria do Santíssimo: quando a arte é imanência
Reconhecimento àquela que é o mito fundante, matriz e nutriz, de nossa tradição naïf.
a rtigo de o pinião: Conflitos da existência
r ECEI ta
• Edição – C&S Assessoria de Comunicação
• Diagramação – Rick Waekmann
• Projeto gráfico – Augusto Paiva
• Impressão – Gráfica De Fato
• Revisão – Ângela Karina
Redação, publicidade e correspondência
Av. Rio Branco, 2203 – Mossoró (RN)
Fones: (0xx84) 3323-8900/99836-5320
Site: www.defato.com/domingo
E-mail: pautadefato@gmail.com
DomIngo é uma publicação semanal do Jornal de Fato. Não pode ser vendida separadamente.
JOSÉ DE PAIVA REBOUÇAS Jornalista
@paiva_reboucas
Quando cheguei aqui nem tinha 17 anos e pouco sabia da função. Devo a dona Milonga os cuidados e o trato para que desenvolvesse bem meus dotes, dados a mim por herança, como dizem. O fato de eu ser morena chama muito atenção, me disseram. Acho isso uma grande bobagem porque, em todos os ambientes que visitei, a maioria é da minha cor, com a mesma origem que eu, não vejo diferença.
Por tempos, eu me escondi de mim, mas hoje, reflito e acho que o que faço é o que sou. Digo isso para me justificar, porque eu poderia ter sido muitas coisas, mas por ser atrevida fiquei aqui, atendendo aos desejos dos outros por um preço cada vez menor. Minha mãe, enquanto foi viva, disse que eu nasci com a safadeza nos olhos. Eu, por muitos anos, sofri para esconder o meu corpo e não confrontá-la. Meu pai dizia que eu era linda e me olhava de um jeito diferente. Acho que por isso, mamãe me batia e me culpava por tudo. Sempre foi fraca da cabeça, talvez de tanto passar fome. Ele também me batia quando chegava bêbado e eu não gostava de seu carinho. Foi ficando mais violento até que morreu esfaqueado pelo meu tio no bar da esquina. Não vi minha mãe chorar, mas sei que ela sofreu, tanto que precisou juntar-se logo com outro homem, mais novo e mais calado.
Viver sem o amor de uma mãe é como não viver. Reinar-se nos recantos até ouvila expulsando você de casa. Mas ela tinha

razão. Eu nunca mereci sua confiança, nem com papai nem com o padrasto calado que me levou para a cama. Entrou sem ser convidado e quando acordei já não tinha reação. De amanhã, apanhei feio com o cabo do ferro de passar. Perdi a confiança de minha mãe que me alimentava e me dava teto. Suportou-me por algum tempo, mas não aguentou a preferência do marido. Eu quis dizer que não tinha culpa e que não adiantava trancar a porta, mas ela só gritava e me jogava coisas.
Devo muito a uma colega de escola o abrigo que me deu nos primeiros dias tirando-me da rua, porém tive de fugir de sua casa para não desmerecer a ela nem a seus pais, caso viessem saber que seu irmão também me perturbava. Mas ele não tinha culpa. Eu é que não soube me dar o respeito. Onde eu passei foi assim, até que decidi entregar-me a esta vida que talvez seja o meu lugar, não por querer, mas por voca-
ção – desígnio, como diz dona Milonga. Disseram que eu poderia ser muita coisa, mas achei este caminho mais fácil.
Faz anos que isso tudo aconteceu e por todo esse tempo me senti suja. Nunca tive a intenção de fazer mal a ninguém, mas feri aos que mais amava. Acho que nasci com uma maldição que não sei bem qual é. Sei apenas que nunca devo ter sido coisa boa.
Agora estou envelhecendo mais rápido que todo mundo. Entrei num caminho sem volta e meu corpo não me obedece mais como eu queria. A cada dia aqui em dona Milonga, está chegando gente nova, até mais nova do que eu quando cheguei, algumas muito mais rebeldes. Mas elas são diferentes. Elas não são como eu que podia ter seguido outro rumo, quem sabe. Eu estudei, fiz quase todo o primário e sei ler e escrever. Sempre fui sabida e destemida, elas não, elas são apenas meninas.
4 d omingo Jornal de Fato

“O Franchising brasileiro atualmente mostra a sua consistência histórica, de ser um setor vigoroso”, revela Cristina Franco, Presidente do Conselho da Associação Brasileira de Franquias – ABF

A cidade de Mossoró recebeu na última quarta-feira, 3 de abril, a presidente do Conselho de Associados da Associação Brasileira de Franchising (ABF), Cristina Franco, por ocasião do II Fórum de Desenvolvimento do Varejo de Mossoró e Região, evento realizado pelo Partage Mossoró nas instalações do Requinte Buffet, reunindo empresários, gestores e autoridades para discutir o cenário econômico e as perspectivas para os setores produtivos da cidade e da região, com foco no crescimento do setor varejista. Cristina Franco foi uma das painelistas da noite e trouxe informações importantes sobre esse segmento, seu crescimento no Brasil, no Nordeste e em Mossoró, que conforme dados apresentados pela presidente, repre-
Fotos: Felipe Alberto
DOMINGO - Como você avalia o atual cenário do mercado de franquias no Brasil?
CRISTINA FRANCO - O Franchising brasileiro atualmente mostra a sua consistência histórica, de ser um setor vigoroso, que crescia a dois dígitos anteriormente à pandemia. Tem toda a interrupção que o Brasil e o mundo sentiram com a pandemia e retoma esse crescimento a dois dígitos a partir de 2022. O crescimento em 2023 sobre o ano de 2022 foi de 13.2%.
Qual é o papel do Conselho da ABF na elaboração de políticas e diretrizes para o setor de franquias?
senta 12% do mercado de franquias no Estado do Rio Grande do Norte, com crescimento de mais de 4% ao ano.
Cristina Franco é também Conselheira de Administração pelo IBGC/ SP, com MBA em Franchising e Varejo – FIA-USP/SP, graduada em Serviço Social – PUC/ SP, sócia da empresa Loctok no segmento de eventos corporativos e da Cuoree Consultoria que realiza projetos de Formatação e Desenvolvimento de Negócios; Planejamento Estratégico; Plataformas de Gestão integradas; implantação e rollout de redes de varejo ou franquias. Na entrevista, Cristina detalha sobre as razões por que as franquias estão cada vez mais presentes como escolha de negócios para quem deseja empreender no Brasil.
O Conselho da Associação Brasileira de Franchising tem um posicionamento de olhar o estratégico para o mercado brasileiro de franquias”
O Conselho da Associação Brasileira de Franchising tem um posicionamento de olhar o estratégico para o mercado brasileiro de franquias. Então, toda a questão do ‘advocacy’, do legislativo, executivo e judiciário que possa interferir no franchising brasileiro é o trabalho do conselho da ABF. Aí implementam-se as diretrizes por meio do seu presidente
executivo e da sua diretoria estatutária. Como essas atribuições, estamos sempre acompanhando questões como a da Reforma Tributária, porque o nosso segmento faz um corte, um ‘cross’, em toda a economia brasileira. Nós temos franquias em treze categorias: saúde, beleza, casa e construção, hotelaria e turismo, entre outras, e, com isso, os impactos
6 d omingo Jornal de Fato
da reforma tributária são diferentes em cada categoria. Assim, cabe ao conselho ter o olhar estratégico, de definir que assessorias econômicas, tributárias e jurídicas trabalhem pelos interesses do franchising brasileiro.
Qual é a importância da inovação e da tecnologia para o setor de franquias?
Inovação E tecnologia estão no DNA do franshising e isso é uma realidade mundial. A gente costuma dizer que o franshising é o irmão mais velho das novas economias porque ele traz, no seu relacionamento de franqueado e franqueador, o conceito de economia compartilhada e colaborativa. Você compartilha resultados, busca soluções conjuntas para que diferentes empresários, o detentor da marca e operador da marca, possam atender os clientes em todo Brasil. Também a gente implementa todas as inovações tecnológicas para que o franqueador possa atender na ponta o franqueado com as dire -
Inovação E tecnologia estão no DNA do franshising e isso é uma realidade mundial”


trizes globais das inovações tecnológicas. Então, você já vê no franshising brasileiro o uso de Inteligência Artificial, o uso de vitrines virtuais, o uso do E-Commerce, a favor do consumidor brasileiro e para a gente no franchising, essa implementação acaba sendo mais rápida, pois nós atuamos em rede e a gente consegue conversar com startups e fornecedores para que essa implementação ocorra em todo o Brasil.
Como as franquias têm contribuído para a geração de empregos e o desenvolvimento econômico do país?
O franchising brasileiro é um grande empregador de jovens para o seu primeiro emprego. Hoje é sabido que Comércio e Serviços ocupa o que na década de setenta era lugar das Indústrias em todo o Brasil, como grande empregador para os jovens que iniciavam a sua vida profissional. Hoje essa busca e esse primeiro
O franchising brasileiro é um grande empregador de jovens para o seu primeiro emprego”
emprego é justamente em Comércio e serviços e é justamente aí que entra o franchising brasileiro, criando oportunidades de empregos para jovens em todas as cidades do Brasil, pois estamos com operações desde o Amazonas até o Rio Grande do Sul. Entregamos, de forma consistente, maior oferta de empregos em todo o território nacional.
Quais são os desafios específicos para que haja mais empreendedores do setor de franquias no Rio Grande do Norte?
O que entendemos é que para o franchising no Rio Grande do Norte crescer ainda mais - atualmente esse crescimento no Estado representa 12% da Região Nordeste – é superimportante que haja um maior conhecimento e que esse conhecimento chegue aos potiguares do que é exatamente o franchising. Com esse conhecimento sobre o que é a nossa indústria é possível se fazer a opção em que segmento e categoria de franquia se quer atuar. Saber que tem possibilidades de investimentos para todos os bolsos. É possível se montar uma franquia com 80 mil reais e também franquias com investimentos de um milhão de reais. Então, é uma plataforma em que se consegue fazer a adequação que você possa dar um passo importante de investimento e isso não vai atrapalhar sua vida. Muito pelo contrário, a assertividade nessas escolhas é enorme.
Como as franquias têm se adaptado às particularidades culturais e econômicas de cada região?
Bom, é importante dizer que o franchising tem que ser uma solução para as pessoas que querem empreender e ter o seu próprio negócio, mas também estar inserido nesse contexto regional e cultural de cada região, de cada cidade. Percebendo dessa forma, avaliando esses aspectos, você consegue fazer um investimento que também é mais seguro, mais estruturado e que tenha a adequação às necessidades regionais. É possível identificar passo a passo com o franqueador, qual a rede de franquia, qual a marca que vai ter aderência, às necessidades de consumo da sua cidade.
A sua vinda a Mossoró durante o segundo Fórum de Desenvolvimento do Varejo de Mossoró e Região Oeste trouxe uma importante mensagem para quem deseja iniciar um negócio no setor de franquias.
É possível se montar uma franquia com 80 mil reais e também franquias com investimentos de um milhão de reais”


Qual a importância de eventos como esses para apresentar esse mercado como sendo viável para a classe empresarial de cidades como Mossoró?
Vimos com esse importante evento uma oportunidade genuína de falar de franchising e empreendedorismo para Mossoró. Franchising é empreender e trazer pra terra de vocês, para Mossoró, marcas que constroem pontes e podem estar em todos os lugares do mundo e se fazem aqui presentes, é uma oportunidade de geração de empregos, de desenvolver a veia empreendedora
O franchising tem que ser uma solução para as pessoas que querem empreender e ter o seu próprio negócio”
que uma mulher, um jovem ou alguém como eu, que sou da economia prateada, por exemplo, que já tenho 60 anos e estou aqui ativa e fundei uma rede de franquias, de poder desenvolver a possibilidade dentro da cidade, trazendo o varejo, nessa parceria e simbiose entre o franchising,
varejo e o shopping center. Quando a gente tem essa oportunidade podemos falar sobre tecnologias de varejo e de muitas experiências para trocar com o público e com possíveis interessados. Ficamos muito felizes com esse convite e Mossoró pode desenvolver muitas oportunidades.


Um resgate requintado, fiel e honesto de reconhecimento àquela que é o mito fundante, matriz e nutriz, de nossa tradição naïf
12 d omingo Jornal de Fato
máRCIo DE lIma DanTaS Professor, escritor e crítico literário Especial para Domingo
Se alguém fosse escrever uma história das artes plásticas no Estado do Rio Grande do Norte teria que obrigatoriamente dar o seu a seu dono, ou seja, outorgar o real valor ocupado por Maria do Santíssimo. Em matéria de arte há de se buscar categorias que são da disciplina conhecida como Antropologia do Imaginário. Assim sendo, a pintora de São Vicente teria de ocupar o lugar que lhe compete, uma vez que uma honesta e não adulatória aná lise da sua profícua e bela obra su gere passar por categorias daquele domínio do conhecimento.
Com efeito, Maria do Santíssimo teria de ser considerada como nos sa mais importante artista plástica. Por quê? Porque sua obra emana de uma necessidade individual e coletiva de expressão, uma imanência que por finda a força teria de se plasmar ante qualquer empecilho ou vicissitude.
de rosas, cravos, cravinas, dedaisde-ouro, ramagens, como melindres ou ervilhas-de-cheiro.
Sim, há inconscientemente uma noção do horror vacui tão caro ao Barroco enquanto estilo histórico, quer dizer, todo o espaço da tela deve ser ocupado. Não parece ser à toa que sua pintura tinha um caráter funcional, servia para forrar baús e
malas de madeira. Podemos cotejar, sem margem de erro, a pintura de Maria do Santíssimo com a imagética barroca da pintora portuguesa Josefa de Óbidos, cujos quadros se regem por uma lógica ornamental, decorativa, mesmo a sua pintura sacra não foge a esse raciocínio.
Com efeito, há uma forte presença do Barroco na obra de Maria

Um filósofo de tradição aristotélica talvez dissesse que as pinturas aparentemente ingênuas de Maria do Santíssimo resultam de uma energia social, buscando de qualquer maneira ser dínames, signo que advém das regiões pelágicas da mente e não pede permissão a quem quer que seja para plasmarse em forma de arte. Do ponto de vista da composição, constatamos uma pintora com pleno domínio do espaço a ser ocupado por elementos tais como burros, capelas, guirlandas de flores e diversas espécies

Maria do Santíssimo teria de ser considerada como nossa mais importante artista plástica”
do Santíssimo. Ela não tinha cons ciência do que fazia, tampouco da qualidade da sua obra, nem por isso deixa de ser, talvez, tendo em vista um caráter, como aludimos, antropológico, seja nossa mais im portante artista plástica. Não à toa a atenção que despertou em críticos eruditos e rigorosos como Walmir Ayala Roberto Pontual, que veio conhecê-la pessoalmente.
Com certeza, como boa sertane ja, deve ter franzido muito os olhos quando diante de diletantes ou crí ticos de arte, o seu interlocutor ao nomear as suas cartolinas pintadas com pincel de talo de folha de coqueiro e usando anilina para colorir os utilitários forros de baús que o esposo vendia anonimamente nas feiras sertão adentro, insistia em rubricá-las com uma nomenclatura a ela outorgada.

Se Dorian Gray é o nosso maior artista plástico, em quantidade e qualidade, Newton Navarro ocupa o lugar de uma importância cimei ra na história da evolução de for mas no nosso circuito das artes, a saber, foi quem mais contribuiu para que chegássemos a grandes artistas como Vicente Vitoriano e Ítalo Trindade (separando, com puro efeito didático, a linha e os ângulos curvos, dionisíacos, nervo sos, de Vitoriano, está para Dorian, como os ângulos retos e abstratos de Trindade está para Navarro).
Nesse sentido, a obra de Newton Navarro é superior à de Dorian Gray, o que este fez foi consolidar o que aquele houvera apontado co mo vanguarda e horizonte, onde as nossas artes plásticas estariam em sintonia com o espírito da época.

Por fim, gostaria de lembrar a

importância dessa nossa artista visual: um resgate requintado, fiel e honesto de reconhecimento àque-
la que é o mito fundante, matriz e nutriz, de nossa tradição naïf: Maria do Santíssimo.
A R t UR L EI t E
Expositor Espírita
prea838998@gmail.com
“Eu vim para que todos tenham vida, e vida em abundancia.”
Jesus (João; 10, 10).
Viver, e não somente existir, eis o grande desafio.
Há algo de capital importância ao homem saber: o que ele é, de onde vem, para onde vai, qual o seu destino. A ideia que fazemos do universo e de suas leis, das obrigações para conosco e o desenvolvimento do orbe, da vida futura, dá-nos uma Fé inabalável no Porvir; por elas dirigimos nossos atos. Consultando-as, estabelecemos um objetivo em nossas vidas e para ele caminhamos.
“Uma vida que não é questionada não merece ser vivida.” (Platão).
“A negação da vida futura suprime também toda sanção moral. Com ela, quer sejam bons ou maus, criminosos ou sublimes, todos os atos levariam aos mesmos resultados. Não haveria compensações às existências miseráveis, à obscuridade, à opressão, à dor; não haveria consolação nas provas, esperança para os aflitos. Nenhuma diferença se poderia esperar, no porvir, entre o egoísta – que viveu somente para si, e frequentemente na dependência de seus semelhantes –, e o mártir ou o apóstolo que sofreu, que sucumbiu em combate para a emancipação e o progresso da raça humana. A mesma treva lhes serviria de mortalha.” (Léon Denis).
O homem, sem a bússola de seus destinos, é viajante que percorre maquinalmente um caminho sem conhecer o ponto de partida nem o de chegada, sem saber por que viaja e que, por conseguinte, qualquer vento o conduz, perdendo tempo e descuidando-se de sua evolução.
Sendo a Terra um planeta de provas e expiações na escala dos mundos – “Na casa de meu Pai há muitas moradas”, exorta-nos o Divino Mestre – é habitada, em sua maior parte, por espíritos, ainda, imperfeitos. A matéria reina soberana em nosso mundo. Curva-nos sob seu jugo, limita nossas faculdades, estanca nossos impulsos para o bem e nossas aspirações para o ideal. Além disso, para entender a dinâmica da vida, observar a lei suprema que rege as almas e os mundos, é preciso saber se libertar dessas pesadas influências, desapegar-se das preocupações de ordem material, de toda ilusão que nos encobrem.
O progresso Moral, independente do intelectual e tecnológico, é a Ascenção do Ser, a sua evolução. Por ainda não atingir tal equilíbrio, e, navegando pelas sendas dos equívocos, dando ênfase ao ter em vez de primar o Ser, o homem se vê à sombra da lei pedagógica de causa e efeito. A depender de nossas necessidades haveremos de conviver com a dor, que é a purificação, a fornalha onde se fundem todos os elementos impuros que nos mancham: o orgulho, avareza, egoísmo, ciúme, preconceito, indiferença; a lista é imensa. É a única escola na qual se refinam as sensações, na qual se aprende a piedade, fraternidade, resignação, per -
dão, caridade, benevolência, entre outras virtudes; necessárias ao progresso Moral. É nos elevando pelo pensamento e, uma firme vontade, pairando, de alguma forma, acima dos detalhes da existência, que perceberemos a verdade, e, encontraremos o caminho.
E, finalmente suplantando a influência negativa da matéria, o Homem, sob a pura luz da razão, entenderá sua verdadeira essência e verá resplandecer seu destino. Esclarecido sobre o objetivo da vida e o porquê das coisas, permanecerá firme, resignado diante da dor; saberá fazê-la servir à sua depuração, ao seu adiantamento. Já não teme a prova, compreendendo ser salutar, que é o choque do despertar, e que é só por esse dilaceramento que poderá ser derramado o fel que está em nós. Se os homens rirem dele, se for vítima da injustiça e da intriga, aprenderá a suportar pacientemente seus males, dirigindo seus pensamentos para nossos irmãos mais velhos: Sócrates bebendo a cicuta, Jesus na cruz, Joana na fogueira. Consolar-se-á no pensamento de que os maiores, os mais virtuosos, os mais dignos, foram às últimas consequências em seus propósitos, deixando seu legado para humanidade.
Comece agora a sua reflexão e pense no amanhã, apoiando-se nos exemplos de mulheres e homens corajosos que se tornaram modelo de felicidade, por ter construído um mundo melhor para todos.
Alegre-se com sua existência e faça-a melhor a cada dia, valorizando os bons e ruins momentos da evolução.
Tempo de preparo: Até meia hora
Rendimento: quatro porções
A velha e boa macarronada muitas vezes pode enjoar. Por isso, procurar variedades no preparo dos pratos e substituir ingredientes por novas combinações pode fazer o ato de cozinhar muito mais prazeroso.
o livro “200 Receitas Gostosas de Pescados” traz sugestões incríveis e combinações deliciosas para preparar peixes de diversas maneiras. Ricamente ilustrado, o título pertence a coleção
Culinária de Todas as Cores que agrada aos leitores pelas dicas e pelo bom preço.
Um dos pratos apresentados no livro é o penne com atum, espinafre e tomate. O resultado é colorido e bastante apetitoso. Com esta refeição fica mais fácil convencer as crianças de comer a verdura que faz ficar forte, como o Popeye.
350 g de penne
2 colheres (sopa) de azeite, mais um pouco para regar
1 unidade cebola picadinha
1 dente de alho amassado
500 g de tomates-cereja cortados ao meio
1 pitada de açúcar (opcional)
250 g de espinafre tenro
2 latas (185 g cada) de atum em azeite escorrido
sal e pimenta a gosto

Cozinhe o penne de acordo com as instruções do pacote.
Aqueça o azeite numa panela, adicione a cebola e refogue em fogo brando até amolecer. Junte o alho e os tomates e refogue por mais 3-4 minutos, até começarem a desmanchar. Tempere o molho com sal e pimenta e, se necessário, um pouco de açúcar.
Ponha o espinafre no molho. Com cuidado, junte o atum, tentando não quebrar demais. escorra a massa e misture ao molho. Regue um pouco de azeite sobre o prato.
Pennecremosocommariscos.Cozinhe350 g de penne de acordo com as instruções da embalagem.Aqueçaumpoucodeazeitenuma panela e junte 1 dente de alho picadinho, 150 ml de vinho branco e 1,5 kg de mariscos limpos (p. 12). Tampe e frite até os mariscos abrirem, descartandoosfechados.Coeereserveocaldo. despejeolíquidonumapanelalimpaejunte200 ml de creme de leite fresco. Apure até ficar com consistência cremosa. escorra o macarrão, tire os mariscos da concha e acrescente tudo ao molho. Tempere com sal e pimenta.
Fonte: Receitas Folha S.Paulo






>> No elenco de “Renascer”, Sophie Charlotte exalta trajetória intensa na televisão
Destaques das séries e conteúdo “on demand”
> Lançada em 1998, "Sex and the City" foi uma das séries mais transgressoras da HBO, retratando o cotidiano de quatro mulheres solteiras, na faixa dos 30 anos, vivendo as dores e delícias cotidianas em uma Nova Iorque efervescente. Uma colunista, Carrie Bradshaw, fala sobre sexo e amor de forma cômica e sincera ao lado das amigas Samantha Jones, Miranda Hobbes e Charlotte York. Depois de muitos pedidos dos assinantes, as seis temporadas chegam ao catálogo da Netflix.
Corpo em guerra (Netflix, ter, dia 9)
Mistura de ficção científica com boas doses de terror, em "Parasyte: The Grey", a Terra está sendo invadida por uma força desconhecida capaz de se disfarçar na multidão sem causar nenhuma desconfiança. Na nova série da Netflix, a protagonista Su-in, interpretada por Jeon So-nee, também foi infectada por um parasita alienígena. Porém, alguma coisa única em seu corpo impediu que ela fosse totalmente dominada pelas forças invasoras. A produção é uma adaptação do mangá "Parasita", de Hitoshi i waaki, que já vendeu 25 milhões de cópias ao redor do mundo.
Dupla dinâmica (Globoplay, qua, dia 10) e xibida originalmente entre 2004 e 2007, " s ob Nova d ireção" chega na íntegra ao catálogo do Globoplay. Criada e protagonizada pela dupla Heloísa Périssé e i ngrid Guimarães, a trama conta a história Belinha, uma dondoca milionária e fútil que nunca trabalhou e está no quarto casamento, quando seu último marido pede a separação e a deixa sem nenhum centavo, apenas com um bar falido no subúrbio. Desolada, ela quase acaba atropelada por Pit, uma taxista cheia de complexos por ainda ser solteira aos 30 anos, que foi colega de escola de Belinha na infância e decide ajudá-la, embora acabe despedida e despejada no mesmo dia. Sem dinheiro ou emprego, as novas amigas decidem reerguer o bar e transformá-lo em uma fonte rentável para sobreviverem, morando no andar acima, onde muitas confusões acontecem a cada episódio. No elenco, l uís Miranda, l uiz Carlos Tourinho e Otávio Müller.
Ajuda extra (Star+, qui, dia 11) a série "a Fábrica de e Ts" acompanha d alí (Jerónimo b est), um garçom que trabalha para um cultista que acredita em vida extraterrestre, que, após um chamado, retorna a o garrio del Cobre, a antiga e abandonada cidade mineradora onde seu pai e seu avô viveram, para receber uma herança que pensa ser a salvação de sua vida. Quando Dalí percebe que a cidade está em ruínas devido a uma dívida milionária que os habitantes têm com o governo, ele decide reacender sua economia, transformando o vilarejo em um destino turístico de uma forma muito particular: revi -

vendo uma antiga crônica sobre a chegada de e Ts ao local. d alí deverá lutar contra todas as possibilidades para impulsionar Ogarrio del Cobre e devolver aos seus habitantes o lar que merecem.
Dublê de vida (Netflix, sex, dia 12)
Tom r ipley é um trambiqueiro de Nova i orque nos anos 1960 contratado por um homem muito rico para viajar para a i tália e convencer o filho dele a voltar para casa. Mas aceitar o trabalho é só o começo de uma teia de trapaças, fraudes e assassinatos. A minissérie é baseada nos best-sellers de Patricia Highsmith sobre Tom r ipley, que já inspirou um longa de sucesso nos anos 1990. " r ipley" é estrelada por a ndrew s cott, d akota Fanning e Johnny Flynn.
Força do céu (Disney+, seg, dia 8)
A animação "Wish: O Poder dos Desejos" chega ao Disney+. O longa é uma cativante história sobre o reino mágico de rosas, onde a sha, uma jovem espirituosa e sonhadora, faz um desejo tão poderoso que é atendido por uma força cósmica: uma pequena bola de energia chamada e strela. Juntas, a sha e e strela enfrentam um inimigo terrível - o governante de rosas, o rei Magnífico - para salvar a sua comunidade e provar que quando a vontade de um ser humano corajoso se conecta com a magia das estrelas, coisas maravilhosas podem acontecer.

Atelevisão sempre teve uma presença constante na trajetória de Sophie Charlotte. Desde que estreou diante das câmeras, a atriz engatou um trabalho no outro.
Nos últimos anos, ela integrou o elenco de inúmeras produções na Globo, como “Ilha de Ferro”, “Passaporte para Liberdade”, “Todas as Mulheres do Mundo” e “Todas as Flores”. Agora, após quase 10 anos longe das novelas na tevê aberta, Sophie retorna ao formato que a consagrou para o grande público. Mas tudo isso com novas visões e percepções de seu trabalho nos estúdios. “Eu quero ter a possibilidade de fazer bons personagens e eu tenho tido esse privilégio. Recebi esse convite para participar de ‘Renascer’ com um sim absoluto. Queria simplesmente me divertir nessa oportunidade. Eu gosto de me sentir desafiada. Cada projeto acaba tendo um Norte. Não tenho um planejamento tão cartesiano, mas eu projeto os meus desejos e acabo mentalizando e visualizando”, afirma.
Em “Renascer”, Sophie vive a sofisticada e sedutora
Eliana, mulher de José Venâncio, papel de Rodrigo Simas. Modelo de sucesso e um tanto paranoica, ela abriu mão da carreira para viver ao lado do marido no Rio de Janeiro. Nunca teve vocação nem vontade para a maternidade, enquanto o sonho de Venâncio era dar um neto ao seu pai. “A Eliana é uma mulher que sabe que tem poder, tem sensualidade e sedução. Ela não é uma mocinha. Mas precisa lidar com sentimentos muito confusos e complexos”, defende.
P – Você estava longe das novelas clássicas, de tevê aberta, há quase 10 anos. Como o convite para “Renascer” fez você regressar ao formato?
R – Estava com saudade dessa sensação de começar um trabalho e construir essa história com o público. “Renascer” veio muito nesse sentido. Quando esse projeto chegou, eu entendi que queria me divertir. Mesmo tendo cenas intensas, meu intuito é diversão. Quero fazer esse ofício com prazer. Curtir essa contação de história. Tenho o privilégio de fazer o que amo. Por isso, valorizo tanto essa oportunidade.

P – A trama de “Renascer” é o terceiro remake que você participa. Como está sendo reconstruir uma história que já está no imaginário popular há tantos anos?
R – Fui atrás de me inspirar e entender essa história. Não conhecia a obra toda, mas sabia do tamanho e da importância dela para a dramaturgia brasileira. “Ti-Ti-Ti” foi cercada de expectativas e “O Rebu” foi muito importante, mas “Renascer” é um fenômeno pela grandiosidade do cenário brasileiro. É um projeto que une muitos preceitos e é uma homenagem ao Benedito Ruy Barbosa.
P – Como assim?
R – Os tempos mudaram, né?
Ainda bem. Minha personagem se transformou bastante nessa passagem de tempo. Os questionamentos da Eliana podem se transformar. Quando saíram as primeiras notícias e chamadas sobre ela, eu fiquei na dúvida sobre qual seria a percepção. Acho que esse vai ser o grande
mistério e a grande beleza de estar, ao mesmo tempo, homenageando o que está no imaginário brasileiro, e que precisa e vai ser respeitado e reverenciado, e refletindo sobre o que mudou e o que precisa mudar. Na história desse núcleo, agora, em 2024, o que acontece? A novela tem essa força, essa potência. Sempre acreditei nisso, que contando histórias, falando de emoção, de paixão, de conflitos, conflitos familiares, a gente consegue trazer para a conversa dentro das casas muitos assuntos que às vezes não chegam de outra forma.
P – Você chegou a conversar com a Patrícia Pillar, que viveu a Eliana na primeira versão, sobre a construção da personagem?
R – Não falei com a Patrícia Pillar, mas assisti a trechos no Globoplay da primeira versão. Eliana se transforma bastante na passagem de tempo de uma versão e outra. Me senti livre para poder criar uma nova Eliana e fazer uma leitura divertida.
close / No elenco de “Renascer”, Lívia Silva faz sua estreia no horário nobre como a intempestiva Teca
Conquistar tudo que se deseja pode ser demorado em qualquer carreira. Michelle Barros sabe bem disso. A jornalista, que hoje divide a apresentação do matinal “Chega Mais” com Regina Volpato e Paulo Mathias, no SBT, começou a sua carreira há mais de 20 anos, dedicada ao hard news e com uma trajetória invejável. No entanto, assim como diversos colegas de profissão, viu seu interesse em se lançar no entretenimento crescer com o passar do tempo. Hoje, o posto que ocupa na emissora de Silvio Santos parece proporcionar uma excelente combinação entre sua experiência à frente de telejornais e seu sonho antigo. “O ‘Chega Mais’ não tinha esse nome para mim, mas era uma vontade há muito tempo. Fiz jornalismo por mais de duas décadas da minha vida, só que sempre com um pé no entretenimento também. Buscava essa leveza no noticiário, nas entrevistas, na apresentação”, entrega a maceioense.
As redes sociais foram ferramentas que, aparentemente, ajudaram a aguçar em Michelle o desejo de se
aventurar em pautas e temas que permitissem uma abordagem diferente da comumente utilizada nos telejornais. “Sempre acreditei que elas permitiriam uma linguagem mais direta e espontânea com as pessoas. Esse formato precisa estar na televisão. Mesclar entretenimento com informação e prestação de serviço é o combo perfeito. Por isso, vemos a internet dar tão certo na tevê”, analisa.
Poder dividir esse momento de vida e de trabalho com Regina e Paulo parece ser proveitoso para Michelle. “A gente está em uma sintonia gigante”, garante. Regina já era uma pessoa que a jornalista conhecia, ao contrário de Paulo. “Ele chegou para somar. Nós três nos unimos de uma forma muito gostosa. É uma oportunidade que o SBT nos abre para apresentar algo novo. Algo para o brasileiro que está em casa ou na rua. São várias horas prestando serviço”, valoriza.
A ideia do “Chega Mais”, segundo Michelle, está nessa informalidade mesmo, criando mais identificação com as pessoas que assistem. “É falar com o público como a gente fala no dia a dia. E a

Regina faz isso muito bem. Por isso, o ‘Chega Mais’ foi irrecusável para mim”, entrega, elogiando a colega de estúdio. O que não significa, porém, que acontecimentos marcantes não entrem em pauta no programa matinal. “Nós três, como jornalistas,
navegamos por esse território. Você tem de ter ciência do momento. Caiu um avião, aconteceu um acidente, as pessoas estão sofrendo, não tem como fazer brincadeira. Falamos do que impacta a vida da população de todo o Brasil”, aponta.
ponto de vista / Sem novidades no formato, sexta temporada mantém “Que História é Essa, Porchat?” como um reduto de sinceridade e bons perrengues
Aorigem do humor de Fábio Porchat é o stand-up comedy. Porém, foram os anos à frente de seu talk-show na Record que fizeram o humorista de fato deixar de lado o desespero de ter de parecer sempre engraçado e se tornar um bom ouvinte. Na saída da emissora em direção ao Grupo Globo, o ator, redator e humorista teve de pensar bem nos próximos passos na carreira. Seria muito fácil se repetir à frente de mais um programa de entrevistas, só que agora contando com toda a estrutura e o casting exclusivo da casa. Porém, em vez
do papo de carreira e projetos que predominam neste tipo de produção, Porchat decidiu focar nas curiosidades que sempre valorizam esse tipo de conversa. Tendo como primeira janela o canal pago GNT e o Globoplay, e posteriormente, a exibição na tevê aberta, sem grandes firulas, o “Que História é Essa, Porchat?” chega à sexta temporada sem grandes novidades no formato, mas fiel ao seu propósito de ter famosos e anônimos compartilhando experiências inesquecíveis, engraçadas e até mesmo assustadoras. Com bom faro e participantes dispostos, a di-
nâmica começa a dar algum sinal de desgaste, mas cumpre bem o seu papel de entreter e fazer rir.
Nas mãos de um humorista um pouquinho mais ególatra, o programa poderia soar um tanto enfadonho. Mas, mesmo cheio de boas histórias e sacadas, Porchat mira o holofote em seus convidados e os deixa brilhar. A boa repercussão das primeiras temporadas, com todos os ingredientes para que parte das histórias viralizassem nas redes sociais, foram fundamentais para que o apresentador conseguisse um time invejável de famosos na fila

de espera para ocuparem uma cadeira dentro do estúdio. Neste sentido, a nova temporada não decepciona e agrega nomes que não costumam frequentar qualquer programa de tevê, casos de Murilo Benício e Angélica. Na contramão, é nítida a repetição de participantes e a presença de personalidades sem boas histórias ou que não se entregam de fato à dinâmica do programa.
Sem tantas alterações no esquema técnico, a sexta temporada valoriza ainda mais presença da plateia, demonstrando um trabalho de préprodução mais apurado, onde a equipe realmente fez o dever de casa para trazer enredos interessantes e que muitas das vezes roubam a cena. Outro ponto que vem ganhando cada vez mais destaque é a comprovação das histórias contadas pelos entrevistados, utilizando fotos e vídeos. Expert em deixar os convidados confortáveis, Porchat consegue tirar as celebridades do pedestal e, além dos risos, exibe também suas facetas mais emotivas e saudosas, valorizando a mistura de sentimentos que cada história carrega. Simples, bem executado e com roteiro afinado assinado por Paula Miller e pelo próprio apresentador, “Que História é Essa, Porchat?” vai além do simples bate-papo ao mostrar que os pequenos contratempos da vida são democráticos e universais.
>> Elas por Elas Globo –18h15
Segunda – Sérgio pede que Maninha o alerte caso tenha notícias de Helena. roberto não se conforma com o sumiço de Vilma. rico e Érica conseguem capturar os agiotas que ameaçavam Wagner. Carol convida Natália para morar com ela. Adelaide mostra a Giovanni lembranças de sua mãe biológica. Carol é homenageada por seu trabalho na universidade. Mário tenta descobrir o paradeiro de Vilma. Helena sequestra Ísis.
Terça – Helena dopa a irmã. Marcos descobre que Helena não está com Sérgio e alerta Giovanni. Adriana se desespera com a possibilidade de Helena estar com Ísis. Helena arma para Ísis e simula que a jovem a atacou. Ísis é detida e liga para Giovanni. Helena comemora o sucesso de seu plano. Marcos e Sérgio procuram por Helena.
Quarta – A emissora não vai divulgar o resumo do antepenúltimo capítulo.
>> Família É Tudo Globo –19h15
Segunda – Vênus fica perturbada com as insinuações de b renda sobre Tom. e lisa questiona l upita sobre o testamento de Frida. Marieta comenta com Vênus que se incomoda com Brenda. Vênus decide chamar os irmãos para ajudar Chicão na obra da Galeria Mancini. Hans exige que lupita espione os primos. Vênus prepara uma surpresa para Júpiter, Plutão, andrômeda e electra, que acabam brigando.
Terça – Vênus se enfurece com os irmãos. Murilo vê as fotos de electra no computador de luca e fica arrasado. Hans destrata Mila. Chantal tenta animar Murilo. ramón tem uma ausência durante uma reunião. Vênus separa os irmãos em duplas para ajudar nas obras da Galeria Mancini. Tom avisa a Vênus que descobriu o paradeiro de Nilton Correia. Chicão leva Andrômeda para um estádio de futebol. e lisa procura Júpiter. Vênus fala para leda sobre suas suspeitas com o acidente de Pedro e estranha seu comportamento.
Quarta – leda passa mal, e Vênus se preocupa. e lisa volta com Júpiter. andrômeda fica com mes de Chicão. Júpiter mente para elisa, e Plutão fica intrigado. Nicole se acidenta, e Plutão a leva para o hospital. Chantal avisa a Jéssica sobre paradeiro de l uca. Chicão consola a ndrômeda.
Tom convida Vênus para sair com ele e seus filhos. Paulina pede para conversar com Pudim e laurinha antes do encontro com a rival. Jéssica flagra e tra e luca juntos.
>> Renascer Globo –21h15
Segunda – Tião Galinha está cismado com o que acredita ter sido uma tentativa de roubo à sua galinha. Joana avisa a Tião que não foram os filhos que mexeram na gaiola. Deocleciano pede a Morena para não contar a ritinha que viu eliana beijar d amião. Kika reage às novas mentiras contadas por Bento, que se dá conta de que perdeu a namorada para sempre. Buba confronta Venâncio com as mentiras que ele mesmo criou. Mariana sente ciúmes de José inocêncio. Mariana diz a inácia que José inocêncio vai ter que tirar a santa de casa, e ameaça deixar a fazenda. Mariana pede a João Pedro que a beije.
Terça – João Pedro resiste à tentação de Mariana, que ameaça deixar José inocêncio. dona Patroa resolve assumir a personagem de Joana e exige que egídio faça o mesmo com Tião Galinha. José i nocêncio e Mariana discutem. i nácia tenta confortar Mariana. Mariana pede a Morena para ficar em sua casa por uns dias. Bento resolve se mudar para são Paulo, e avisa a egídio que seu cacau está na fazenda do pai. augusto agradece lu por ter lhe aconselhado a conversar com Zinha. João Pedro se espanta quando vê Mariana na casa de Morena, afirmando que largou José inocêncio.
Quarta – Morena diz a João Pedro que Mariana sente ciúmes do afilhado. José inocêncio não contra o facão que fincou ao pé do Jequitibá. José i nocêncio sonha com Maria s anta pedindo para trazer seus filhos de volta à fazenda e para perdo ar Mariana. A imagem de Belarmino aparece para Mariana, que absorve todo o ódio que o avô sentia por José inocêncio. João Pedro avisa a Mariana nunca ficará com ela pelo respeito ao pai. Mariana volta para casa e promete pra si que conseguirá passar as terras que eram de sua família para nome.
>> A Infância de Romeu e JulietaSBT –20h30
Segunda – Glaucia reúne Bernardo e Vera e diz que, a partir de agora, ela e Fred têm plenos poderes na Monter Holding. Bernardo e Vera acham estranho leandro colocar Glaucia no comando, ainda mais internado. Mauro se encontra com o detetive luciano e ele explica que laura o contratou para buscar a família. O detetive declara que não é fingimento e que laura tem memória a curto prazo. luciano comenta que fez um vídeo explicativo sobre a história dela para ela ver todo dia ao despertar.
Terça – dimitri, ian e Nath pegam água da Fonte da Juventude para dar a Fausto, ele virar criança e assim, entrar no Mundo da imaginação. Mauro diz a Mariana que laura não está fingindo sobre a memória e que ela só precisa ser lembrada todo dia quem é. Mariana pede um tempo no namoro. Bernardo questiona a posição de Glaucia na Monter Holding. romeu encontra Julieta, que deseja ver leandro no hospital. dimitri, ian e Nath entregam uma garrafa com água da Fonte da Juventude para Pórcia e pedem para ela dar a Fausto sem ele perceber.
Quarta – leandro diz para Julieta que o tempo hospital fez ele pensar mais sobre a vida, filhos, presa e até em Hélio. leandro afirma que a briga entre as famílias foi longe demais e que deseja uma conversa séria com Hélio. leandro abraça meu e Julieta e expõe que aprova a amizade deles. Glaucia exige que enzo sirva um café. Julieta comen ta com Hélio que foi visitar leandro. Vera fica brava com romeu. alex, ian e Mauro fazem um mural fotos e um vídeo com a história de laura para ela todos os dias. Cansada por Mariana não perdoar Monteiro, Julieta diz que quer morar com Daniel.
resumo Quinta – A emissora não vai divulgar o resumo do penúltimo capítulo.
Sexta – A emissora não vai divulgar o resumo do último capítulo.
sábado – reprise do último capítulo. preocupa. ciúPlutão leva sobre o ndrômeda. filhos. aurinha lec-
Quinta – luca não deixa electra enfrentar Jéssica. Murilo avisa a Vênus que a primeira audiência sobre os desvios feitos por Mathias foi marcada. Paulina se irrita por não conseguir influenciar os filhos. Andrômeda decide entrar em um concurso para impressionar Chicão. Catarina critica Vênus por querer investigar a morte de Pedro. e lectra pergunta se luca acredita em sua inocência. Jéssica procura Hans.
Sexta – Jéssica faz uma proposta para Hans. lupita pensa em ajudar Chantal a ficar com Murilo. lulu se revolta ao ser questionada sobre Pedro por Vênus. Guto pede para Chicão ajudá-lo a conquistar l upita. l ulu faz uma revelação sobre Nanda para Vênus. Nicole pede a Plutão para apresentá-la a Tom. Guto se irrita com a técnica que Chicão pretende usar com ele. s em querer, l upita sabota o jantar que preparou para Murilo e Chantal. electra, Andrômeda e Plutão encontram um dinheiro e descobrem que é de Júpiter. Vênus questiona Nanda sobre a ameaça feita a Pedro.
Sábado – Vênus se desculpa com Nanda pelas acusações. Júpiter mente para os irmãos sobre como conseguiu seu dinheiro. Murilo e Chantal passam mal com a comida feita por lupita. Vênus teme que suas ex-madrastas estejam envolvidas com a morte de seu pai. Chantal beija Murilo. Mila ouve uma conversa de Hans com um advogado sobre os netos de Frida. lupita desmaia depois de salvar Júpiter. Andrômeda e Chicão se prendem, sem querer, a uma resina. electra pede para conversar com l uca. Hans responde à proposta de Jéssica. Paulina arma plano com a intenção de culpar Vênus.
Mariana enJosé para perdopara sentia que Mariana conseguirá seu
Quinta – e liana sugere que Mariana seja mais esperta caso queira conquistar as terras que eram de seu avô. Zinha percebe um clima entre lu e José Augusto, que acompanha a professora na saída da escola. egídio e José inocêncio discutem no bar de Norberto após provocação do pai de sandra.
sexta – eliana ensina estratégias para Mariana. as duas conversam e inácia estranha a proximidade das duas. egídio comenta com Marçal que vai demitir funcionários da sua fazenda. eliana bajula José inocêncio. lu chama a atenção de Zinha pela cena de ciúmes com José Augusto. Mariana resolve seguir as ideias de e liana. Natasha, Janaína e Maitê, amigas de Buba, organizam uma festa surpresa para ela e contam com a ajuda de Teca.
Sábado – Venâncio fica incomodado com a presença das amigas de Buba, que fica triste com a situação. Mariana sonha com João Pedro e José inocêncio flagra os dois juntos. ela acorda assustada. eliana e damião se encontram às escondidas na fazenda. Piolho, um agiota a quem José Bento deve dinheiro, está atrás do filho de José inocêncio para cobrar dívida. Buba está feliz e mais leve com a companhia das amigas. Zé Augusto e Zinha deixam de lado as mágoas e ela ensina a ele sobre a lida com o cacau. Deocleciano se lamenta com José i nocêncio por egídio ter comprado o cacau deles por conta do acordo com José Bento.
Quinta – No hospital, leandro declara para Hélio que deseja recomeçar a amizade. Mas eles discutem feio e os batimentos cardíacos de leandro aceleram. Patrick vê um cartaz do workshop de dança de Kessya Soares e decide fazer aula. Branca segue Chilique e Fê Dengosa e descobre o esconderijo deles. laura expressa a Mauro que quer um emprego. Mauro diz para ela trabalhar na parte administrativa da academia dele.
sexta – Patrick dança com Kessya e o menino aprende bons passos. dimitri, ellen, ian e Nath conseguem fazer Fausto ingerir a água da Fonte da Juventude e ele volta a ser criança. Glaucia cobra Vera por ter tratado Pórcia mal e diz que está preocupada com a reputação da família. O quadro de saúde de leandro piora. Karen nota que Mini tem interesse na mãe e planeja um encontro. Dimitri, ellen, ian e Nath convencem Fausto a ir ao Mundo da imaginação. Vera pede para o detetive luciano descobrir quem é o dono do perfil Castanheira no Bafo.

Vilma Melo passou as primeiras duas décadas de sua carreira focada no teatro. Conhecida professora de Artes Cênicas e premiadíssima nos palcos, foi só a partir de 2010 que ela passou a investir na televisão. Destacando-se em personagens secundários de produções como “Joia Rara” e “Segunda Chamada”, foi com muito afinco que a atriz chegou ao posto de protagonista de “Encantado’s”, cuja a segunda temporada já está disponível no Globoplay. A série criada pela dupla Renata Andrade e Thais Pontes é o primeiro fruto da oficina de humor para roteiristas negros, realizada pela Globo em 2018. A trama é ambientada em um galpão no subúrbio carioca que durante o dia é supermercado e à noite vira a quadra da Escola de Samba Joia do Encantado. Vilma vive a obstinada Olímpia, que divide o comando de ambos os empreendimentos com seu irmão, o inconsequente Eraldo, de Luis Miranda. “Eu amo a Olímpia. Ela é um protótipo da mulher preta brasileira. Ela é arrimo familiar, extremamente amorosa, empreendedora e justa. Mas, como nem tudo são flores, ela também sofre o que muitas de nós, mulheres pretas nesse país, sofremos: a baixa autoestima. Ela, tão capaz em tantos aspectos,

não consegue enxergar a sua beleza e confiar em seu potencial”, resume.
Carioca criada em Realengo, bairro da Zona Oeste do Rio de Janeiro, Vilma é formada em Artes Cênicas pela UniRio e apareceu pela primeira vez na tevê na minissérie “Cidade dos Homens”, de 2002. Os inúmeros compromissos com os palcos e os convites pouco atraentes para a televisão fizeram da atriz uma presença bissexta no vídeo.
P – Depois de uma primeira temporada que fez sucesso no streaming e na tevê aberta, como você encara a continuidade de um projeto como “Encantado’s”?
R – A segunda temporada de “Encantado’s” tem uma simbologia muito forte. Em um tempo em que o streaming tem tantas opções e ideias na fila, a continuidade de qual-
R – Com certeza. E tira a série do contexto da ação ou violência. Hollywood tem diversas produções com famílias pretas protagonistas que não estão diretamente ligadas a violência e outros estereótipos. É raro no Brasil visitarmos este lugar e “Encantado’s” faz isso, mostra um subúrbio como ele é, onde pessoas trabalham, sofrem, ganham dinheiro, perdem dinheiro, sorriem, desfilam, namoram, sustentam suas famílias, fofocam, lutam pelo dia a dia sem perder o rebolado. E esse é o encanto.
P – Sua relação com a tevê vem se intensificando nos últimos anos. Como você encara o posto de protagonista?
quer projeto merece ser celebrada. Ainda mais uma produção como essa, que tem um elenco majoritariamente negro, recheada de atores desconhecidos do grande público. É sinal de que o povo preto vende, é talentoso.
P – Como assim?
R – Quando um time de atores pretos conquista uma oportunidade como essa, a gente agarra esse ofício com afinco. Nunca sabemos se virá outra chance, já que para nós elas sempre são limitadas e passageiras. A repercussão da série é incrível e vem muito da identificação do público. A trama é um recorte da vida cotidiana da classe trabalhadora do país e se utiliza do humor para mostrar dramas e dilemas.
P – Você acha que o tom cômico intensifica o apelo popular da história?
R – É uma vitória pessoal, mas também coletiva. A televisão está presente na casa da maioria da população brasileira, são milhões de aparelhos ligados vendo o seu rosto estampado, ouvindo a sua voz falando para e com eles. Por tanta visibilidade, acredito sim que “Encantado’s” será sempre lembrada como uma virada de página.
P – Em que sentido?
R – É uma questão de valorização. Nesta história, muitos de nós migramos de repetidos papéis de subserviência para personagens com relevância, com histórias próprias e cheias de nuances. Figurar na liderança deste supermercado que dá nome a série obviamente é de uma imensa felicidade. E fazer parte dessa virada de página é e sempre será muito significativo. Sou muito agradecida por isso.
raio-x / Kenny Albertoni defende a liberdade feminina nas relações amorosas com a bem resolvida Lia do remake de “Elas por Elas”
Opróprio nome já indica: “Elas por Elas” é uma novela pensada principalmente para o público feminino. Por isso mesmo, volta e meia surgem tramas ou personagens que valorizam as mulheres e o empoderamento delas. É esse o caso de Lia, papel de Kenny Alberti, que entrou recentemente na novela de Thereza Falcão e Alessandro Marson para uma participação especial. Na história, ela dá vida à irmã do Delegado Rico, vivido por Pedro Caetano, uma mãe divorciada que se sente livre para não se prender a nenhum homem, decidindo apenas se divertir com eles. E seu caminho cruza justamente com o do personal trainer Edu, interpretado por Luis Navarro, que traía a ex-mulher Érica, atuação de Monique Alfradique, com diversas amantes – algumas que sequer sabiam que o professor de Educação Física era casado. “Lia é uma mulher forte, independente, alegre e de bem com a vida. Já esteve em relações, tem um filho, mas agora quer se relacionar com liberdade, sem precon-
ceitos, rótulos ou imposições. Ela acredita no amor livre”, defende Kenny.
A chance de integrar o elenco de “Elas por Elas” acabou realizando um antigo desejo da atriz curitibana. “Acompanho o trabalho da Tereza e do Alessandro há muito tempo, sempre quis fazer parte de um projeto deles”, conta, mencionando a dupla de autores. Assim que fechou sua participação no folhetim, vibrou por se tratar de uma produção protagonizada por mulheres. “É uma novela que aborda o quanto nós, mulheres, somos muitas vezes subjugadas pelo simples fato de sermos mulheres. Além disso, é um remake de um grande sucesso dos anos 1980. Eu nasci exatamente em outubro de 1982, enquanto a primeira versão estava no ar. Isso me fez sentir parte dela”, entrega.
Antes mesmo de começar a gravar “Elas por Elas”, Kenny já acompanhava a novela das 18h da Globo. Primeiro, porque costuma mesmo ser telespectadora desse tipo de produção. Com isso, tornou-se menos preocupante chegar com todo o elenco

já entrosado e perto de se despedir do trabalho. “Foi um pouco mais fácil. Já conheço a trama e os personagens do meu núcleo. O bom de entrar na reta final é que as histórias estão se resolvendo e o público, torcendo para os desfechos. Tem uma energia de ‘final de campeonato’ que é bem gostosa”, descreve.
Kenny Alberti iniciou no teatro ainda na adolescência. No entanto, precisou dar um tempo para se dedicar à família, depois que engravidou. Aos 30, após empreender e experimentar o mundo corporativo, voltou a se dedicar exclusivamente à carreira artística. Na televisão, ela já gravou cenas em “Além da Ilusão”, “Um Lugar ao Sol”, “Pega-Pega”, “Haja Coração” e “Êta Mundo Bom”, todas na Globo.
Nome: Kenny Ellen Alberti.
Nascimento: 19 de outubro de 1982, em Curitiba, no Paraná.
Atuação inesquecível: Como Fabiana, na peça “Na Hora do Adeus”, drama psicológico de Jarbas Capusso Filho.
Interpretação memorável: Irandhir Santos em “Renascer”, como Tião Galinha.
Momento marcante na carreira: “Estar em um set totalmente poliglota e com uma das maiores atrizes do Brasil, Maria Fernanda Cândido, quando filmamos o longa ‘O Traidor’”.
O que falta na televisão: “Oportunidades para atores e atrizes de verdade, de formação, de teatro, que fazem do seu ofício um propósito de vida”.
O que sobra na televisão: “Influencers e celebridades da internet, que muitas vezes sequer subiram no palco. Isso prejudica demais o próprio desempenho deles, além de não contribuir em nada com a obra artística”.
Com quem gostaria de contracenar: “Com dona Fernanda Montenegro. É um sonho”.
Se não fosse atriz, seria: Escritora/roteirista.
Ator: Irandhir Santos.
Atriz: Fernanda Montenegro.
Novela: “Avenida Brasil”, escrita por João Emanuel Carneiro.
inside / Ana Clara comandará novo talent-show musical do horário nobre da Globo
Exatos 88 dias foram responsáveis por transformar a vida de Ana Clara. Pouco depois de deixar o confinamento do “Big Brother Brasil”, em 2018, a apresentadora começou a construir uma inesperada carreira diante das câmeras. Além de estrear como repórter e apresentadora do “Vídeo Show”, ela também esteve à frente de diversos programas na Globo, no Multishow e no GNT e, em dupla com Tadeu Schmidt, comandou por dois anos o “Big Day”, dia especial da Globo que revela, ao vivo e durante toda a programação, os participantes da edição do “BBB”.
Após acumular uma boa bagagem na tevê nos últimos anos, Ana Clara se prepara para seu primeiro grande voo solo na televisão aberta. A partir do segundo semestre, ela estará à frente do inédito talent-show “Estrela da Casa”. “Eu sonhava ter um programa diário, sempre falei que essa era a minha vontade. Mas, a gente coloca como algo distante. E quando acontece... Não sei, acho
que minha ficha ainda não caiu (risos). Eu fico rindo sozinha, porque é muito louco! Não é algo rápido, mas, quando chega, você fala: meu Deus! É como um filho. Acho que eu fiquei gerando um filho nesses últimos anos e, agora, ele está nascendo”, vibra.
Com formato inédito e original da Globo, o “Estrela da Casa” nasce da união de dois elementos: convivência e competições musicais. Desta vez, entre as provas, disputas, votação popular e transmissão 24 horas, um elemento a mais na competição: será possível acompanhar a rotina de um artista que sonha em conquistar seu lugar no mercado da música. Dos ensaios às performances semanais que decidem o destino dos cantores no game, os encontros e treinamentos com quem é referência no ramo, até a chance de dividir o microfone e estar pertinho de seu ídolo, em um encontro musical exclusivo.
O público vai viver junto os bastidores que envolvem o mundo do mercado fonográfico, enquanto cada can-

didato disputa, além do título de Estrela da Casa, um prêmio em dinheiro, gerenciamento de carreira e turnê pelo Brasil. “Estou ansiosa para construir esse programa junto ao público. A música é um assunto que traz muita alegria para as pessoas e também é o sonho de muita gente. Acho que vai ser uma junção boa. Estou animada e espero que as pessoas também estejam”, explica.
Assim como acontece no
“BBB”, o “Estrela da Casa” contará com exibições ao vivo todos os dias. Em 2023, Ana Clara comandou, ao vivo, o “Panelaço”, do GNT. Ela confessa que está animada para retornar ao formato em tempo real. “Eu amo fazer programa ao vivo. A rotina é muito especial e é um termômetro muito grande porque, ao mesmo tempo em que estamos no ar, estamos com o público, conversando”, ressalta.
bastidores / Com elenco estrelado, “Justiça 2” viaja até Planalto Central para contar novas histórias que subvertem a legalidade
Lançada em 2016, a série “Justiça” logo chamou atenção pela densidade das histórias de Manuela Dias, o capricho visual da direção de José Luiz Villamarim e o elenco recheado de grandes estrelas da Globo, contando com nomes como Marina Ruy Barbosa, Marjorie Estiano, Leandra Leal e Cauã Reymond, entre outros, em personagens arrojados e longe do trivial. Além de prestígio e sucesso de audiência no Globoplay, a produção ganhou um Emmy Internacional na categoria Melhor Série e logo despertou na Globo um desejo por uma continuação, “Justiça 2”, que chega ao Globoplay na próxima quinta, dia 11 de abril.
Apesar de toda a pompa em torno da ideia, esta segunda temporada do projeto só foi mesmo confirmada em 2022 e sucessivamente adiada por questões de agenda dos envolvidos. Somente oito anos depois da primeira temporada, finalmente foi possível estrear uma nova leva de episódios.“‘Justiça’ não é uma série sobre leis, mas sobre a possibilidade de que exista justiça. A própria ideia de justiça é uma ferramenta civilizatória que viabiliza a vida em
sociedade. A vida mostra que isso é apenas um condicionamento teórico. Dentro desse contexto, as tramas da série são uma investigação do que sobra na vida de uma pessoa depois que a Justiça morde seu quinhão”, conceitua a autora.
Com 28 episódios, a série mantém seu formato de entrelaçar histórias com diferentes protagonistas, mas troca a ambientação litorânea de Recife, capital de Pernambuco, pela estética concreta de Brasília e Ceilândia, cidades do Centro-Oeste brasileiro. O enredoagoraacompanhaatrajetória de Balthazar, Jayme, Geíza e Milena, papéis de Juan Paiva, Murilo Benício, Belize Pombal e Nanda Costa, respectivamente, que são presos no mesmo dia, e apresenta a retomada da vida de cada um ao sair da prisão, sete anos mais tarde.
Os personagens vão em busca de uma justiça que vai além da lógica dos processos judiciários. Para Gustavo Fernandez, que assume o posto de diretor artístico da nova temporada, o respeito ao formato entrega unidade à antologia, mas novas histórias e conceitos estéticos renovam “Justiça 2”. “Os personagens e as tramas são completamente novos e surpreendentes. O

fato de a série agora se passar no Distrito Federal condicionou uma linguagem específica. Brasília, com as suas linhas retas e suas perspectivas, naturalmente pediu uma câmera com movimentos mais lentos e planos mais abertos”, ressalta Fernandez.
Além das tramas se interligarem, outro elemento que conecta as duas temporadas é a presença de Kellen, de Leandra Leal. A personagem aparece nas quatro novas histórias principais, em momentos e relações diferentes com os protagonistas e retorna à série como administradora de uma agência de viagens. A verdade é que o negócio é uma fachada para a agência de garotas de programa Las Primas. “A Kellen tem uma moral muito própria de sobrevivente e está mais maternal, mais conectada a outras mulheres e mais defensora das amigas também. Você a vê tendo outros tipos de relação com as mulheres comparado a temporada original,
onde ela nitidamente insistia em uma competição feminina”, analisa Leandra.
Guardadas as devidas proporções, a personagem Kellen funciona como um alter ego da autora e por isso ganhou uma sobrevida na história. “Eu brinco que ela não tem nada a ver comigo, mas tem tudo a ver comigo. Ela tem uma espécie de senso prático sobre as coisas e eu acho que é um charme têla na história tantos anos depois”, valoriza Manuela.
Com elenco ainda formado por nomes como Marco Ricca, Alice Wegmann, Marcello Novaes, Maria Padilha, Fábio Lago, Danton Mello, Júlia Lemmertz e Paolla Oliveira, entre outros, a primeira parte das gravações em Brasília e Ceilândia começaram em março de 2023 e se estenderam por dois meses. Driblando o caráter meramente político e administrativo local, a direção de “Justiça 2” privilegiou as regiões mais periféricas e pouco exploradas do planalto central.
> Jackson Antunes está bastante contemplativo ao longo das gravações de “Renascer”. O ator, que esteve na primeira versão da obra criada por Benedito Ruy Barbosa, tem relembrado alguns momentos da novela original. “Outro dia fiquei apenas observando as gravações e olhando em estado de encantamento. O Bruno (Luperi, autor) tem uma troca muito bonita e traz uma visão moderna da obra do avô”, valoriza. Na história, Jackson interpreta Deocleciano, um dos fiéis escudeiros de José Inocêncio, papel de Marcos Palmeira. “É uma novela que conversa com os dias de hoje. Estamos trazendo essa obra prima para o ano de 2024”, aponta.
Referência da tevê
atualmente à frente do “Hora do Faro”, rodrigo Faro voltará aos cinemas. e le protagonizará o filme “ s ilvio”, que tem estreia marcada para 5 de setembro. o longa, que conta a trajetória do comunicador silvio santos, conta com direção de Marcelo Antunez.
Obra do horário nobre a novela “em Família” chegará ao catálogo do Globoplay. a trama assinada por Manoel Carlos estreia no próximo dia 15. Julia lemmertz, Gabriel Braga Nunes e Bruna Marquezine integram o elenco.
Vínculo afetivo
Mesmo de saída do sbT, e liana seguirá como madrinha do Teleton. a apresentadora, que seguirá no ar até junho, retornará para comandar a maratona beneficente. após quase 15 anos, e liana decidiu rescindir seu contrato com a emissora de Silvio Santos.
Gente que chega antes de voltar ao ar na segunda temporada de “ o s o utros”, original Globoplay, eduardo s terblitch integrará o elenco do programa “Papo de segunda”, do GNT. além do ator e humorista, a produção também contará com o músico russo Passapusso. eles estarão ao lado do âncora João Vicente, e de Francisco bosco. o programa estreia no próximo dia 22.
No elenco
a atriz Magali biff estará no elenco da trama de “a Caverna encantada”, nova novela infantil do sbT. o folhetim é escrito por iris abravanel. o folhetim estreia no segundo semestre.
Produção internacional
Ainda em abril, o Globoplay disponibilizará a quinta temporada de “s.W. a .T. - Força de intervenção”. a produção internacional é estrelada por shemar Moore, Jay Harrington e alex russell.
estrelada por Marco luque, a primeira temporada de “No Corre” chegará à tevê aberta. a produção de humor estreia no dia 28 de abril.

Tudo de melhor sabrina sato encara o “The Masked singer brasil” como um momento de lazer. A apresentadora integra a bancada de jurados do “reality show” comandado por i vete s angalo. “acho que acima de tudo eu me divirto muito fazendo o ‘The Masked s inger’. o programa tem um super alto astral. É tudo muito colorido e alegre, todos fazer bolão para acertar quem é a pessoa mascarada, discutem”, explica sabrina, que busca fazer uma preparação antes de cada gravação. “Gosto de me preparar com a minha turma de trabalho, a gente conversa bastante. Faço fono e descanso também”, completa.
